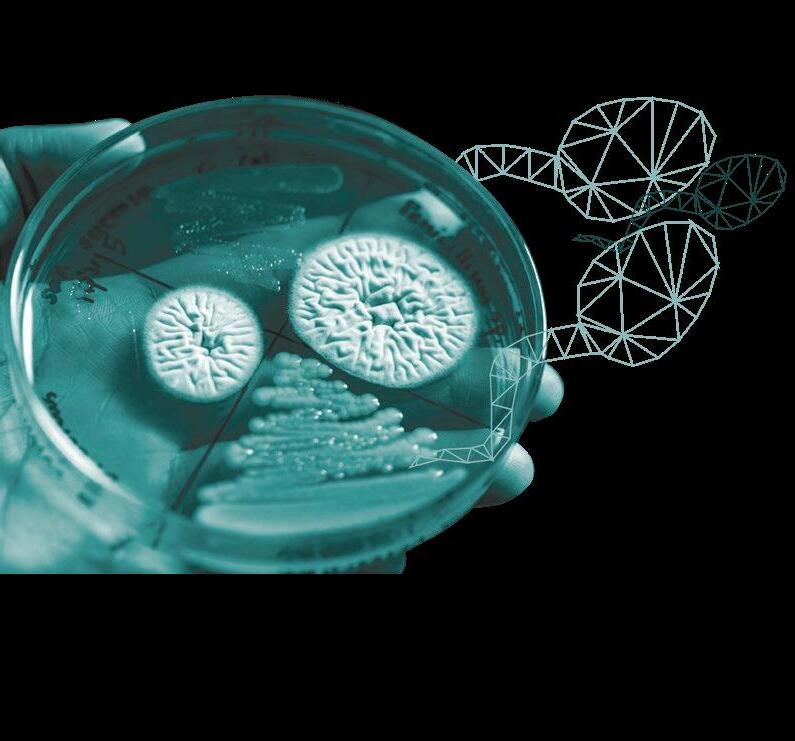
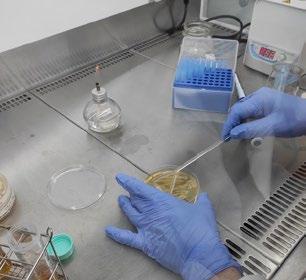
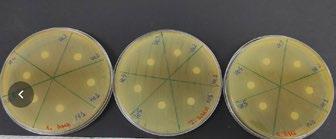

ARMADO Y CONSOLIDACIÓN DE EQUIPOS DE TRABAJO: LA SOLUCIÓN A LA ROTACIÓN DE PERSONAL p. 28
MARZO 2024
Nuevos Horizontes



Nutrigenómica Porcina
Fundamentos Esenciales



Fibra Dietética en Cerdos y Micotoxinas
Visión a la Transformación en los próximos años
Avances Claves



Impacto de densidad y CM de comederos en la etapa de engorde
Alternativas Sin Antibióticos
Nutrición de precisión


Clima y Nutrición
Restricción Alimentaria en Cerdas Gestantes y Enzimas Exógenas

Subproductos Agroindustriales en la Dieta Porcina
¡Súmate
PIGTIONARY! porcinews.com/abc/abc-nutricion
a
DESAFÍOS Y PERSPECTIVAS PARA EL SECTOR PORCINO LATINOAMERICANO EN 2024
El sector porcino latinoamericano se enfrenta a una serie de desafíos cruciales en el año 2024, que requieren una respuesta estratégica y proactiva por parte de los productores de la región.
Uno de los desafíos más apremiantes es la necesidad de mejorar la bioseguridad en las granjas porcinas para prevenir la propagación de enfermedades, como la peste porcina africana, que pueden tener un impacto devastador en la industria.
Además, la volatilidad en los precios de los insumos, como el maíz y la soja, plantea desafíos significativos para los productores porcinos, que deben encontrar formas de gestionar eficientemente sus costos de producción en un entorno económico incierto.
La competencia global también representa un desafío, ya que los productores latinoamericanos deben mantener altos estándares de calidad y eficiencia para competir con los principales actores del mercado internacional.
A pesar de estos desafíos, el sector porcino latinoamericano en 2024 también presenta grandes oportunidades, como el crecimiento continuo de la demanda de carne de cerdo a nivel mundial y la posibilidad de expandir la presencia en nuevos mercados.
EDITOR AGRINEWS LLC
PUBLICIDAD
Luis Carrasco +34 605 09 05 13 lc@agrinews.es
Félix Muñoz +34 618 18 00 16 felix@mediatarsis.com
COMITÉ TÉCNICO
Laura Batista
Roberto M.C. Guedes
REDACCIÓN

Noelia Ammendolea
ATENCIÓN AL CLIENTE secretaria@grupoagrinews.com
ADMINISTRACIÓN
Mercè Soler admin@agrinews.es
Precio de suscripción anual: 90 USD
info@grupoagrinews.com porcinews.com grupoagrinews.com
Revista de distribución gratuita
DIRIGIDA A VETERINARIOS Y TÉCNICOS
Depósito Legal Porcinews B17989-2015
ISSN (Revista impresa) 2696-8169
La sostenibilidad sigue siendo un tema crucial para el sector porcino en 2024, con la necesidad de reducir el impacto ambiental de la producción y adoptar prácticas más respetuosas con el medio ambiente. La presión creciente sobre los recursos naturales, como el agua y la tierra, requiere una gestión responsable por parte de los productores para garantizar la viabilidad a largo plazo de la industria porcina en la región.
Con una estrategia sólida, un enfoque en la innovación y la sostenibilidad, y una respuesta eficaz a los desafíos presentes, el sector porcino latinoamericano está bien posicionado para enfrentar el futuro con determinación y éxito.
ISSN (Revista digital) 2696-8177
Revista trimestral
La dirección de la revista no se hace responsable de las opiniones de los autores.
Todos los derechos reservados.
Imágenes: Noun Project / Freepik/Dreamstime
porciNews A.Latina Marzo 2024 1

CONTENIDOS América Latina porciNews
04
Selección y manejo de futuras reproductoras hiperprolíficas
Fernando Pandolfo Bortolozzo,Gabriela Piovesan Zanin,Rafael da Rosa Ulguim, Ana Paula Gonçalves Mellagi
Faculdade de Veterinária, Universidade Federal do Rio Grande do Sul (UFRGS), Setor de Suínos, Porto Alegre 90540-000, RS, Brazil. Artículo traducido y adaptado de “Bortolozzo, F.P.; Zanin, G.P.; Ulguim, R.d.R.; Mellagi, A.P.G. Managing Reproduction in Hyperprolific Sow Herds. Animals 2023, 13(11), 1842. doi. org/10.3390/ani13111842”
Esta revisión describe los principales desafíos asociados con la hiperprolificidad durante el período en el que se seleccionan las hembras de reposición y durante el período de gestación.
14
Placentación: Análisis del impacto en el peso fetalParte 1
Leticia P. Moreira, Saffir D.
Fernandes, João Vitor L. Ferreira, Abner L. Shinkawa, Dayanne K. O. Pires, Isadora M. S. de Oliveira, Stephanny R. Rainha, Tulio C. C. de Alkmim , Fernanda R. C. L. Almeida
Instituto de Ciências Biológicas da Universidade Federal de Minas Gerais
El periodo de gestación es fundamental para determinar la salud y el desarrollo de los lechones. Por otra parte, el mantenimiento de unas condiciones morfológicas y fisiológicas adecuadas es esencial para un desarrollo prenatal satisfactorio.
22
Operación supervivencia neonatal. Reducción de la mortalidad en sistemas de parideras alternativas

Emma Baxter
Investigadora experta en Comportamiento y Bienestar Animal, Scotland’s Rural College - SRUC
Mejorar la supervivencia neonatal es un objetivo permanente en la producción porcina, siendo el enfriamiento, la inanición y el aplastamiento por parte de la cerda las principales causas de mortalidad de lechones nacidos vivos.
28
Armado y consolidación de equipos de trabajo: la solución a la rotación de personal

Gastón Imola
Facilitador y Coach, Liderazgo en granjas porcinas
Las personas son el centro de la productividad, son los que gestionan los recursos de las instalaciones, la genética, la nutrición y la sanidad.
2 porciNews A.Latina Marzo 2024
34
Nuevas formulaciones en diluyentes espermáticos: variaciones en la concentración de azúcares y uso de péptidos para combatir las resistencias antimicrobianas
Pablo Fernández
Veterinario responsable de desarrollo de producto, ARQUIMEA
Si hablamos de reproducción animal, mantener la calidad seminal a lo largo del tiempo es crítico para el éxito de la reproducción.
40
Abordando el desafío del óptimo rendimiento de las cerdas lactantes
Chantal Farmer
Traducido y adaptado de Farmer C. Achieving optimal sow performance, still an ongoing challenge in 2022. Anim Front. 2022 Dec 14;12(6):53-55. doi: 10.1093/af/vfac064. PMID: 36530507; PMCID: PMC9749810.
Los lechones mueren durante el proceso de parto o al comienzo de la lactancia. El problema de la producción inadecuada de leche de las cerdas aún persiste.
50

Prop 12: Exigencias normativas para exportar carne de cerdo a California
M Verónica Jiménez G.
MV MSc Etología y Bienestar Animal
Muchos se preguntan ¿Cómo cambiarán los requisitos de espacio para la cría de cerdos? ¿Qué implicaciones tendrá esto en términos de costos, infraestructura y prácticas de cría?
60
El uso de grasas oxidadas en la alimentación porcina: riesgos y consideraciones. Parte 1/3
Gerardo Ordaz Ochoa, María Alejandra Pérez Alvarado, Luis Humberto López Hernández
Centro Nacional de Investigación Disciplinaria en Fisiología y Mejoramiento Animal, INIFAP, México
Las grasas y los aceites son componentes esenciales en la dieta de los cerdos, aportan energía, ácidos grasos esenciales, contribuyen a las características sensoriales del alimento e inciden en la calidad de la carne.
66

Explorando la microbiota y biomarcadores de salud intestinal
Guillermo Ramis
Veterinario y Profesor Titular de la Universidad de Murcia
La integridad intestinal se define como el mantenimiento de la estructura histológica que regula la internalización de moléculas a través de la mucosa del intestino.
El Grupo de Comunicación Agrinews quisiera resaltar y distinguir el notable empeño y apreciable aporte y colaboración de los autores de los artículos. El esfuerzo compartido hace posible que podamos ofrecer a nuestros lectores un contenido técnico de calidad.
Reiteramos por tanto nuestro más sincero agradecimiento.
porcinews.com
3 porciNews A.Latina Marzo 2024
SELECCIÓN Y MANEJO DE FUTURAS REPRODUCTORAS
HIPERPROLÍFICAS
Artículo traducido y adaptado de “Bortolozzo, F.P.; Zanin, G.P.; Ulguim, R.d.R.; Mellagi, A.P.G. Managing Reproduction in Hyperprolific Sow Herds. Animals 2023, 13, 1842. https://doi.org/10.3390/ani13111842”


porciNews A Latina Marzo 2024 | Selección y manejo de futuras reproductoras hiperprolíficas 4 manejo
INTRODUCCIÓN
El genotipo de la cerda moderna difiere dramáticamente en términos de perfil productivo y metabólico de los genotipos de hace 20 o 30 años. Las líneas maternas modernas tienen un rendimiento de parto impresionante, con un aumento de 4,5 lechones nacidos en total durante el período 2006-2019 [ 1 ] o 6,7 lechones nacidos en total durante el período 2000-2020 [ 2 ]
Uno de los principales impulsores de este aumento continuo en el tamaño de la camada es la mejora genética, que llega a las granjas a través de hembras de reemplazo.
Además, a lo largo de los años, las primerizas modernas se han vuelto más delgadas, más eficientes en cuanto a alimentación y de crecimiento más rápido que las primerizas de décadas anteriores.

Por lo tanto, las estrategias correctas en la selección, crianza e inducción de la pubertad de los animales de reemplazo son eslabones importantes para un flujo constante de futuras reproductoras de alta calidad hacia el hato reproductor.
A pesar de los esfuerzos en la selección genética, la hiperprolificidad estuvo acompañada de una disminución en el peso de los lechones al nacer.
Como resultado, los lechones se volvieron más vulnerables, aumentando la mortalidad previa al destete y comprometiendo su crecimiento potencial.
Con camadas más grandes, la duración del parto aumentó, lo que resultó en más mortinatos y distocia, y comprometió la salud puerperal de la cerda.
Además, la cantidad de calostro disponible por lechón ha disminuido y el número de lechones nacidos vivos supera el número de tetas funcionales.
De esta manera, las camadas más grandes trajeron enormes desafíos. El catabolismo lactacional es intenso en cerdas con más lechones lactantes. Así, existen grandes desafíos para mantener a estas hembras con condiciones corporales adecuadas al destete y durante todo el período de gestación.
Además, los lechones pueden experimentar más competencia por el acceso a la ubre durante el período de lactancia.
Esta revisión se centra en aspectos de las cerdas hiperprolíficas, destacando los principales cambios en la fisiología reproductiva de estos animales y proporcionando un enfoque basado en evidencia para mejorar las intervenciones de manejo.
porciNews A Latina Marzo 2024 | Selección y manejo de futuras reproductoras hiperprolíficas 5 manejo
FUTURAS REPRODUCTORAS
Un flujo constante de futuras reproductoras de alta calidad y bien manejadas en el plantel reproductor tiene un impacto significativo en la eficiencia de este, mejorando la longevidad, estabilizando la estructura censal y permitiendo que la granja alcance sus objetivos [ 3 ]
La selección exitosa para una alta prolificidad se asoció con aumentos en la proporción de cerdos con bajo peso al nacer y una mayor mortalidad pre destete [ 4 , 5 ] .
Además, el peso al nacer de la futura hembra reproductora afecta directamente su productividad y longevidad en el hato.
Las hembras nacidas con un peso inferior a 1 kg y seleccionadas para entrar en el hato reproductor muestran resultados satisfactorios en términos de inicio de la pubertad y tasas de parto. Sin embargo, el número de lechones producidos al tercer parto y la longevidad se vieron comprometidos [ 6 ] .
Más recientemente, cuando se exploró la “camada de origen” en el contexto del creciente número de lechones con bajo peso al nacer, un gran porcentaje de crías con bajo peso al nacer procedían de una minoría de cerdas con un bajo peso de camada extremo y repetible. -fenotipo de peso al nacer [ 7 ]

Estas cerdas probablemente tengan un desarrollo placentario reducido y una deficiente comunicación entre la madre y el embrión [ 8 ] .

La selección genética y las mejoras en la sanidad, instalaciones, manejo y nutrición han dado lugar a futuras reproductoras con un aumento de peso y un desarrollo corporal excepcionales, particularmente en el período entre el destete y la inducción de la pubertad [ 4 ]
El genotipo moderno de rápido crecimiento tiene menos tejido adiposo que sus antecesores, lo que modifica las demandas metabólicas de por vida [ 1 ]
porciNews A Latina Marzo 2024 | Selección y manejo de futuras reproductoras hiperprolíficas 6 manejo
Normalmente, desde el destete hasta la pubertad, las futuras reproductoras se alimentan ad libitum y, en condiciones de producción, su nutrición no siempre es diferente a la de los cerdos de engorde.
Por lo tanto, las primerizas modernas están creciendo rápidamente y se han convertido en un verdadero desafío, particularmente considerando la proporción de primerizas que exceden el peso corporal objetivo en la pubertad y los impactos negativos del sobrepeso en el desempeño posterior.

GANANCIA DE PESO
Un proceso adecuado de estimulación de la pubertad es esencial para proporcionar un suministro constante de primerizas elegibles para el servicio [ 9 ]

La aparición de la pubertad puede ser estimulada a edades más tempranas por varios factores ambientales y de manejo [ 12 , 13 ], pero los intentos de asociar la pubertad con un peso crítico [ 14 , 15 ], tasa de crecimiento (GR) [ 16 ], grasa [ 14 , 17 ], o el tejido magro [ 17 ] siguen siendo controvertidos, ya que están fuertemente influenciados por el genotipo.
El efecto macho es un factor crítico que influye en el logro de la pubertad en las primerizas, y la exposición diaria a una rotación de verracos maduros y con alta libido maximiza la respuesta [ 9 , 18 ] .
Datos anteriores de Beltranena et al. [ 19 ] sugieren que cuando la ganancia media diaria (GMD) a lo largo de la vida es inferior a 0,55 kg/día, la pubertad se retrasa. Datos más recientes respaldan que con una alimentación sin restricciones durante la fase de crecimiento/acabado, es poco probable que la GMD limite la edad del primer estro [ 20 , 21 ]
Cerdas primerizas con mayor GMD (723 g/día) mostraron pubertad antes
que las cerdas primerizas con menor GMD (577 g/ día)
Una mayor cantidad de ellas alcanzó la pubertad a los 190 días de edad (95% frente a 76%)
Mostrando la importancia de la GMD de por da como un factor que anticipa la pubertad, principalmente cuando las primerizas están expuestas a los verracos a una edad temprana
Una GMD de por vida cercana a 800 g/d no parece tener efectos perjudiciales sobre el inicio de la pubertad.
porciNews A Latina Marzo 2024 | Selección y manejo de futuras reproductoras hiperprolíficas 7 manejo
A pesar de las diferencias entre las líneas genéticas, generalmente se acepta que el peso objetivo de la primera cubrición es de 135 a 150 kg [ 3 , 9 , 24 ] y de 13 a 15 mm de espesor de grasa dorsal a la edad de 220 a 240 días. [ 25 ]
Al prestar menos atención al espesor de grasa dorsal y a la edad, las primerizas que alcanzan este peso objetivo con al menos un estro registrado previamente y adaptadas al estatus sanitario del plantel pueden ser inseminadas independientemente de la edad y el nivel de grasa dorsal [ 3 , 26 ] .
Suponiendo un aumento de peso materno de 35 a 40 kg durante la primera gestación, las primerizas alcanzarían >180 kg después del parto, lo que protege contra los efectos perjudiciales de la pérdida de tejido magro durante la primera lactancia [ 27 ] .
No hay ventajas en criar primerizas demasiado pesadas ya que tendrán sobrepeso al momento del parto, con mayores demandas nutricionales durante la lactancia y a lo largo de su vida productiva [ 3 ], comprometiendo la tasa de parto en el segundo parto [ 21 ]
Las primerizas con sobrepeso también se asocian con problemas de locomoción durante los tres partos y una mayor incidencia de muertes fetales [ 21 , 28 ], probablemente asociadas con mayores dificultades en el parto.
Por lo tanto, desde un punto de vista práctico, estos animales deberían ser inseminados antes, respetando el peso objetivo [ 26 ], o se podrían utilizar estrategias nutricionales durante la fase de crecimiento para reducir la GMD de estas primerizas.
Estas estrategias pueden estar asociadas con una reducción en la relación Lys-energía en la dieta [ 29 ] o una restricción del 25% en la ingesta de energía [ 30 ]


porciNews A Latina Marzo 2024 | Selección y manejo de futuras reproductoras hiperprolíficas 8 manejo
ALIMENTACIÓN
Está bien aceptado que mantener un estado metabólico positivo en el período previo al primer servicio parece ser otro paso crítico para optimizar el rendimiento reproductivo del hato [ 9 ] .
Sin embargo, los requisitos de los genotipos modernos para una estrategia de flushing nutricional (aumentar el consumo de alimento durante el período previo a la inseminación) para aumentar la tasa de ovulación son inciertos.
Más recientemente, se observó que la alimentación abundante después del estro puberal sigue siendo importante para mejorar la tasa de ovulación de las primerizas de reemplazo modernas [ 28 ]
Los autores observaron que la alimentación intensa de las futuras reproductoras durante los ciclos 1 y 2 antes del servicio (2,1 vs. 3,6 kg/d) aumentó el peso corporal y el espesor de grasa dorsal, mientras que la tasa de ovulación en el tercer estro aumentó al aumentar el nivel de alimentación en los ciclos 1 o 2.
Sin embargo, la supervivencia de los embriones se redujo cuando las primerizas fueron alimentadas con 3,6 kg/d durante el ciclo previo al servicio.

Además, se observó que el peso de las futuras reproductoras influye en el tamaño de la camada, y un bajo espesor de grasa dorsal tendían a responder mejor a un período más largo con una alta asignación de alimento pre servicio que las hembras más gordas [ 31 ]
Aunque se necesita más investigación, los resultados disponibles hasta ahora demuestran que realizar una alimentación intensa durante el primer ciclo después del estro puberal produce un aumento en el número de ovulaciones y en el tamaño potencial de la camada, pero probablemente no sea crítico para aquellas que tengan el peso objetivo de servicio.


porciNews A Latina Marzo 2024 | Selección y manejo de futuras reproductoras hiperprolíficas 9 manejo
Controlar la fase de gestación para evitar fallos reproductivos
El tipo de alojamiento, las condiciones ambientales, el sistema de alimentación y el estado de salud durante la fase de gestación son los desafíos más importantes hoy en día en el mantenimiento de la gestación.
Alojamiento
El alojamiento de las cerdas gestantes en corrales colectivos fue el principal cambio adoptado a nivel mundial en los últimos 10 años.
El tamaño óptimo del grupo, el momento de mezcla y el sistema de alimentación no están determinados con precisión para los corrales colectivos.
Existe un consenso en que la mezcla de cerdas no debe ocurrir durante la etapa sensible al estrés de la implantación del embrión [ 36 ], que comienza 11 a 12 días después de la inseminación [ 37 ] .
No se observaron diferencias en el desempeño reproductivo cuando se mezclaron cerdas 4 semanas después del servicio en comparación con las cerdas alojadas en jaulas [ 38 , 39 ] .
Sin embargo, se observaron respuestas contradictorias al comparar cerdas mezcladas poco después de la inseminación con aquellas agrupadas 4 semanas después de la inseminación [ 36 , 38 , 39 , 40 , 41 ]
Esta diferencia entre los estudios podría relacionarse parcialmente con una variación en el tiempo en el que se mezclaron las hembras.
El desempeño reproductivo no se vio afectado en algunos estudios que mezclaron cerdas 4 días en comparación con 30 días después de la inseminación [ 36 , 40 ]

Sin embargo, cuando la mezcla se produjo entre los días 3 y 10 después de la inseminación en comparación con la mezcla posterior (≥30 días) o el mantenimiento en jaulas individuales, se observaron disminuciones en las tasas de concepción y partos [ 38 , 39 ].
Los últimos estudios citados consideraron un amplio rango entre la inseminación y el día de la mezcla, lo que podría afectar el desempeño reproductivo.
Por lo tanto, la mezcla cerca de los días de la inseminación no parece ser perjudiciales en términos de pérdida gestacional [ 42 ] cuando las granjas realizan alojamiento en grupo poco después de la inseminación.

porciNews A Latina Marzo 2024 | Selección y manejo de futuras reproductoras hiperprolíficas 10 manejo
Alimentación
El sistema de alimentación es probablemente el principal desafío a la hora de definir la recomendación para el alojamiento grupal y mitigar los impactos negativos sobre el desempeño reproductivo.
Proporcionar condiciones óptimas para el acceso individual al alimento en corrales colectivos es esencial durante la fase de gestación, ya que este es un período de ajustes en el puntaje de condición corporal (CC) y se realizan diferentes programas de alimentación.
El control de la CC en corrales colectivos es más difícil en comparación con las jaulas individuales, especialmente si se adopta la mezcla de hembras poco después de la inseminación.
La clasificación social o el espacio de alimentación en los sistemas de alojamiento grupales pueden dar como resultado hembras con restricción o sobrealimentación.
En cerdas de parto 1 y 2 alojadas en corrales colectivos y mezcladas poco después de la inseminación, se observó una reducción lineal en el total de lechones nacidos cuando se proporcionó un aumento en la ingesta diaria de alimento (1,8, 2,5 o 3,2 kg/d) desde el día 6 al 30. de gestación [ 28 ] .
Sin embargo, en una revisión sistemática, Leal et al. [ 43 ] concluyó que proporcionar energía en exceso del requisito de mantenimiento durante la gestación temprana no perjudica el rendimiento reproductivo, como se sugiere en otros lugares [ 44 ]
Por el contrario, como se analizó en otro estudio [ 44 ], la restricción alimentaria durante los primeros 30 días de gestación resultó en un mayor riesgo de perder la gestación. Por lo tanto, se debe evitar la restricción alimentaria al comienzo de la gestación.

En cerdas jóvenes destetadas, la estrategia de alimentación recomendada es proporcionar 1,5 veces el requerimiento energético para el mantenimiento y prevenir el deterioro reproductivo [ 28 ] .
Los problemas reproductivos relacionados con el aumento del consumo de alimento entre los días 30 y 90 de gestación no son motivo de preocupación. Sin embargo, se espera que el estrés causado por disputas o restricciones alimentarias comprometa el rendimiento reproductivo [ 45 ]
porciNews A Latina Marzo 2024 | Selección y manejo de futuras reproductoras hiperprolíficas 11 manejo
Algunos efectos negativos atribuidos al estrés social sobre el mantenimiento del embarazo pueden estar relacionados con cuestiones nutricionales [ 44 ]
Por lo tanto, se debe promover un mayor consumo de alimento entre los días 30 a 90 de gestación para evitar la restricción alimentaria y recuperar la CC. Días 30 a 90 de gestación
A partir del día 90 de gestación, se adoptó ampliamente un aumento en los niveles de alimento (bump-feeding) para mejorar el peso al nacer de los lechones, considerando el mayor crecimiento de los fetos en esta fase y el mayor número de lechones en cerdas hiperprolí cas.
Sin embargo, los estudios que utilizaron cerdas primerizas hiperprolíficas demostraron que la estrategia de alimentación progresiva no fue eficaz para promover un aumento en el peso de los lechones al nacer [ 46 , 47 ] y, en algunos casos, redujo la ingesta voluntaria de alimento durante la lactancia [ 46 , 48 ]
El aumento en el consumo de alimento al inicio de la gestación proporcionó más nutrientes para un mejor desarrollo placentario. Sin embargo, el peso placentario total, la eficiencia placentaria y el peso al nacer de los lechones no se vieron afectados por los diferentes niveles de alimentación o fases de gestación.
Moreira et al. revisaron otras estrategias para aumentar el peso de los lechones al nacer, incluidos los aminoácidos utilizados en el tercer trimestre de gestación. [ 49 ] quienes no indicaron efectos beneficiosos independientemente del tipo de aminoácido.
Desafíos futuros
En un futuro próximo, se alojarán más cerdas en corrales colectivos en todo el mundo. Las comparaciones entre sistemas de alimentación asociados con otros factores, como la densidad o el tamaño del grupo en corrales colectivos, y su impacto en el desempeño reproductivo son complejas y los estudios respectivos son escasos.
Así, las empresas están desarrollando modelos de instalaciones para alojamiento grupal basados en observaciones prácticas del bienestar y el desempeño reproductivo.
En nuestra experiencia, el modelo que ha sido bien adoptado en las condiciones brasileñas considera boxes cortos abiertos para el acceso individual al comedero, un piso parcialmente enrejillado, un tamaño de grupo de 15 a 20 hembras con un mínimo de 1,5 y 2 m2 /animal para gestación de primerizas y cerdas, respectivamente.



porciNews A Latina Marzo 2024 | Selección y manejo de futuras reproductoras hiperprolíficas 12 manejo
Estado sanitario
Los problemas locomotores en alojamientos grupales pueden aumentar, reduciendo el rendimiento reproductivo y aumentando el sacrificio por cojera [ 50 ] .
Una rutina de cuidado individual diario de los animales es crucial para un tratamiento temprano, evitando pérdidas de gestación, problemas de bienestar y muerte de las cerdas.
La mortalidad de las cerdas ha sido una preocupación en los últimos años por múltiples razones [ 51 ]. El prolapso de órganos pélvicos (POP) es una de las principales razones de muerte, con signos clínicos que ocurren en la fase final de la gestación y estructuras prolapsadas al parto y después del parto [ 52 ]
El número total de lechones nacidos (lo que indica una alta prolificidad) se evaluó como un factor de riesgo de prolapso y no se asoció con el problema [ 53 ]. La etiología del POP no está completamente determinada, pero se informó que una CC baja es un factor de riesgo importante [ 54 ] .
Además, las granjas que utilizan un mayor consumo de alimento durante la última etapa de la gestación para cerdas que tienen una puntuación de condición baja tuvieron tasas de POP más bajas en comparación con las granjas que no utilizan una estrategia de alimentación combinada.
Por lo tanto, es necesario un ajuste correcto de la CC durante la fase de gestación para evitar el POP y reducir la mortalidad, ya que las granjas con tasas de parto bajas se asocian con una alta mortalidad de las cerdas [ 55 ]
Selección y manejo de futuras reproductoras hiperprolíficas
DESCÁRGALO EN PDF

DESCARGAR BIBLIOGRAFIA


porciNews A Latina Marzo 2024 | Selección y manejo de futuras reproductoras hiperprolíficas 13 manejo

PLACENTACIÓN: ANÁLISIS
DEL IMPACTO EN EL PESO FETAL – PARTE I
Leticia P. Moreira, Saffir D. Fernandes, João Vitor L. Ferreira, Abner L. Shinkawa, Dayanne K. O. Pires, Isadora M. S. de Oliveira, Stephanny R. Rainha, Tulio C. C. de Alkmim , Fernanda R. C. L. Almeida Instituto de Ciências Biológicas da Universidade Federal de Minas Gerais
Introducción
El periodo de gestación es fundamental para determinar la salud y el desarrollo de los lechones. Por otra parte, el mantenimiento de unas condiciones morfológicas y fisiológicas adecuadas es esencial para un desarrollo prenatal satisfactorio.
El desarrollo en el periodo prenatal puede estar modulado por diversos factores, como:
Genéticos
Nutricionales
Morfofuncionalidad del útero y la placenta.
Esta reducción hace que el feto no exprese su potencial de crecimiento para la edad gestacional, dando lugar a una condición conocida como restricción del crecimiento intrauterino (RCIU).
En esta afección, el flujo sanguíneo se envía mayoritariamente al cerebro, órgano clave para la supervivencia, en detrimento de otros órganos.
En la especie porcina, el RCIU se presenta de forma severa, pudiendo afectar hasta el 30% de los lechones nacidos en una camada. En condiciones adversas, el feto utiliza una serie de estrategias para sobrevivir, entre ellas una reducción del metabolismo.
14 Reproducción porciNews A Latina Marzo 2024 | Placentación: Análisis del impacto en el peso fetal - Parte 1

CARACTERÍSTICAS ESTRUCTURALES DE LA PLACENTA
La placenta es el principal órgano responsable del intercambio de nutrientes, metabolitos y gases respiratorios entre la madre y el feto.
Además, produce hormonas, citoquinas y otras sustancias que afectan al crecimiento y desarrollo del feto durante la gestación.
El RCIU es responsable de elevadas tasas de mortalidad en las primeras semanas de vida y de un menor aumento de peso a lo largo del desarrollo, lo que conlleva importantes pérdidas económicas para el sector.
Existen pruebas de que la insuficiencia placentaria es la principal causa de esta afección en los cerdos, ya que el tipo de placenta, epiteliocorial difusa, prácticamente no permite el contacto entre la sangre materna y la fetal.
Por lo tanto, la caracterización de la arquitectura placentaria es crucial para comprender la RCIU y el correcto desarrollo de la camada.
La placenta porcina se clasifica en:
Difusa
Plegada
No invasiva
Epiteliocorial, en la que no hay invasión de tejido fetal en el endometrio materno.
La placentación epiteliocoorial es el tipo más superficial (no invasiva) y el epitelio uterino permanece intacto durante toda la gestación.
15 Reproducción porciNews A Latina Marzo 2024 | Placentación: Análisis del impacto en el peso fetal - Parte 1
La placenta epiteliocorial está formada por seis capas celulares:
Vasos maternos
Tejido conjuntivo
Epitelio endometrial
Epitelio trofoblástico
Tejido conjuntivo y
Vasos fetales
que separan la sangre materna de la fetal (Figuras 1 y 2).

Fig. 1: La placenta epiteliocorial, presente en el cerdo, está formada por seis capas de células: (1) Capilares endometriales (vasos endoteliales maternos), (2) Intersticio endometrial (tejido conjuntivo), (3) Epitelio endometrial, (4) Epitelio trofoblástico, (5) Intersticio coriónico (tejido conjuntivo), (6) Capilares coriónicos (vasos endoteliales fetales). Fuente: Alvarenga-Dias & Almeida (2021)

La placentación (formación de la placenta) comienza con la implantación, adhesión y migración celular, que conducen a la unión del trofectodermo (membrana fetal) al epitelio endometrial materno.
Este proceso incluye la rápida expansión y desarrollo del corion (trofectodermo) y la alantoides entre los días 18 y 30 de gestación. La fusión del corion y la alantoides se produce entre los días 30 y 60 de gestación y, entre los días 60 y 70, se completa el desarrollo placentario en términos de peso, superficie y número de areolas placentarias.
Las extensas modificaciones que forman las crestas coriónicas (placentarias) y las correspondientes invaginaciones endometriales dan lugar a pliegues que, a su vez, aumentan la superficie de la asociación uteroplacentaria.
16 Reproducción porciNews A Latina Marzo 2024 | Placentación: Análisis del impacto en el peso fetal - Parte 1 Fetal (corion) EC Materna epitelio endometrial 1 2 3 4 5 6 CC
La bicapa epitelial (trofoblasto y epitelio endometrial) es capaz de formar más pliegues placentarios a partir del 30º día de gestación. Estos pliegues se hacen cada vez más complejos y largos a medida que avanza la gestación.
Las depresiones del epitelio de la luz y del trofectodermo reducen la distancia entre la sangre materna y la fetal, acortando así la distancia de difusión a través de la (Figura 2).


Figura 2: Microfotografía que muestra la interfase materno-fetal en el día 45 de gestación en cerdos. Tinción HE. 1 Membrana corioalantoidea - pliegue primario, 2 Membrana corioalantoideapliegue secundario, 3 Endometrio - pliegue primario, 4 Endometrio - pliegue secundario, 5 Glándula endometrial, 6 Vasos uterinos. Reis 2021.
Con la formación de los pliegues placentarios, aparecen dos tipos de células trofoblásticas placentarias:
células trofoblásticas columnares, situadas en la parte superior de los pliegues placentarios, y
células trofoblásticas cuboidales, situadas en la parte inferior y en los laterales de los pliegues. .
Además, la formación de pliegues placentarios puede aumentar la superficie de interacción maternofetal para proporcionar una nutrición adecuada al feto en crecimiento.
Así pues, los pliegues placentarios tienen un gran impacto en la eficiencia placentaria, que influye en el desarrollo fetal. Sin embargo, los cambios más drásticos se producen a nivel estructural, en la densidad vascular y en la altura de las células que componen la propia interfase.
17 Reproducción porciNews A Latina Marzo 2024 | Placentación: Análisis del impacto en el peso fetal - Parte 1 3 2 1 4 5 6
DINÁMICA DE LA GESTACIÓN: FACTORES QUE INFLUYEN EN LA ESTRUCTURA DE LA PLACENTA
EDAD GESTACIONAL
La demanda energética de los cerdos aumenta drásticamente a lo largo de la gestación. Por lo tanto, el transporte de nutrientes al feto debe ser cada vez más eficiente. Esto implica reducir la distancia recorrida en la interfase, así como dar prioridad al transporte por difusión pasiva, en el que no se gasta energía.
La creciente demanda de oxígeno conduce a un aumento de la actividad angiogénica, a través de la activación del VEGF y otros factores de crecimiento vascular.
Para satisfacer la dinámica de esta demanda, la estructura placentaria experimenta cambios que favorecen esta optimización. Se evaluó la morfología placentaria en diferentes etapas del embarazo:
Temprana (25 y 30 días)
Intermedia (40, 60 y 70 días)
Avanzado (90 días) y
Término (114 días)

Los resultados mostraron que las células de la interfase, el epitelio endometrial en el lado materno y el trofoectodermo en el lado fetal, disminuían en altura a medida que avanzaba la gestación, midiendo inicialmente entre 21-25µm, disminuyendo rápidamente a alturas inferiores a 2µm en la placenta a término (Figura 3)
 Figura 3: Longitud HDD (distancia de difusión hemotrófica) de los lados materno y fetal de la interfase a los 25 días; HDD = 11,4 µm (a), 40 días; HDD = 15,94 µm (b), 60 días; HDD = 7,42 y 3,72 µm (c) y 114 días; HDD = 2,46, 1,93 y 1,62 µm (d). Se observa una disminución de la altura de la capa celular del epitelio endometrial (columnar). BV, venas; EG, gránulos electrodensos; FM, mesénquima fetal; F/M I, interfase materno-fetal; MV, microvellosidades; StE, estroma; EU, epitelio uterino. Escala: 5 µm. Cristofolini et al. (2017).
Figura 3: Longitud HDD (distancia de difusión hemotrófica) de los lados materno y fetal de la interfase a los 25 días; HDD = 11,4 µm (a), 40 días; HDD = 15,94 µm (b), 60 días; HDD = 7,42 y 3,72 µm (c) y 114 días; HDD = 2,46, 1,93 y 1,62 µm (d). Se observa una disminución de la altura de la capa celular del epitelio endometrial (columnar). BV, venas; EG, gránulos electrodensos; FM, mesénquima fetal; F/M I, interfase materno-fetal; MV, microvellosidades; StE, estroma; EU, epitelio uterino. Escala: 5 µm. Cristofolini et al. (2017).
18 Reproducción porciNews A Latina Marzo 2024 | Placentación: Análisis del impacto en el peso fetal - Parte 1
DIMORFISMO SEXUAL
Además, demostraron el desarrollo vascular a lo largo de la gestación, con la formación de nuevos vasos aumentando en las regiones más cercanas a la interfase en las últimas etapas de la gestación, así como un aumento en el número de vasos de menor calibre, como se muestra en la Figura 4.
Además de la dinámica estructural de la placenta a lo largo del desarrollo intrauterino, otros factores durante la gestación pueden influir en la arquitectura y función placentarias, como el dimorfismo sexual, el tamaño de la camada y la salud de la hembra porcina.
En general, entre los mamíferos, el sexo del feto influye en el peso al nacer, siendo los machos más pesados que las hembras, factor que se observa al principio de la gestación.

En los cerdos, los fetos machos tienen un ritmo de crecimiento más rápido, que persiste durante toda la gestación, así como un mayor volumen de líquido amniótico. Estos factores hacen pensar que existen diferencias en la función placentaria relacionadas con el dimorfismo sexual de los fetos.
Figura 4: Intervalos de área vascular y su distribución en las diferentes edades gestacionales. El intervalo 2, con un área vascular entre 100 y 500µm², prevalece en casi todas las edades, y su cantidad aumenta significativamente hacia el final de la gestación. Int 1: 1-100 µm², Int 3: 5002000 µm², Int 4: 2000-10000 µm², Int 5: 10000-50000 µm², Int 6: 50000-300000 µm². Adaptado de Cristofolini et al. (2017).
19 Reproducción porciNews A Latina Marzo 2024 | Placentación: Análisis del impacto en el peso fetal - Parte 1 Días de gestación 700 650 600 500 550 400 450 300 350 200 250 100 150 0 30 40 90 114 60 50 Int 1 Int 2 Int 3 Int 4 Int 5 Int 6 Cantidad de vasos sanguíneos
En varias especies es posible observar diferencias en el desarrollo fetal entre machos y hembras.
En la especie humana, por ejemplo, los machos presentan desventajas en su respuesta a condiciones uterinas adversas, y los embarazos de varones están más relacionados con un aumento de la prematuridad, la preeclampsia y la diabetes gestacional.

En el cerdo, la relación entre el sexo del feto y el desarrollo de la placenta es muy dinámica. Aunque en los días gestacionales 50 y 104 no es posible detectar diferencias estructurales entre las placentas de fetos machos y hembras, en el día gestacional 70, el peso de los fetos machos es superior (Figura 5)
Miometrio
Líquido amniótico
Líquido alantoico
Placenta
Endometrio
Placenta
Endometrio
En cerdos, varios estudios han demostrado que los machos recién nacidos tienen una mayor mortalidad predestete y son más susceptibles a las enfermedades, a pesar de su mayor peso, en comparación con las hembras. Esto revela un posible papel de la placenta en este escenario.
El estudio realizado por Stenhouse et al. (2019), utilizando células placentarias porcinas (día gestacional 60) cultivadas in vitro, demostró que las células placentarias de los conceptus femeninos tenían una mayor capacidad para establecer conexiones entre sí
 Figura 5: Representación de los conceptus porcinos hembra (rosa) y macho (azul) en el entorno intrauterino. Adaptado de Stenhouse, Bazer y Ashworth (2022)
Figura 5: Representación de los conceptus porcinos hembra (rosa) y macho (azul) en el entorno intrauterino. Adaptado de Stenhouse, Bazer y Ashworth (2022)
20 Reproducción porciNews A Latina Marzo 2024 | Placentación: Análisis del impacto en el peso fetal - Parte 1
Estos resultados, a su vez, sugieren que las placentas asociadas a fetos hembra en el día gestacional 60 producen más factores angiogénicos que los fetos macho.
Por tanto, podemos considerar que comprender los mecanismos que controlan el crecimiento fetal es extremadamente importante para reducir la prevalencia de lechones con bajo peso al nacer y contribuir así a optimizar la cadena de producción porcina.
Los resultados contradictorios encontrados pueden deberse a diversos factores, como la raza de los animales estudiados y, en consecuencia, una mayor variabilidad biológica. Se necesitan más estudios que evalúen los factores angiogénicos placentarios y la metabolómica del líquido amniótico, comparando machos y hembras, para dilucidar mejor esta cuestión.
La primera parte del artículo “Placenta: comprender su papel en la determinación del peso de los fetos machos y hembras” destacaba la estructura de la placenta en los cerdos.
La segunda parte del artículo examina los factores que contribuyen a la ineficacia de la placenta.

Placentación: Análisis del impacto en el peso fetal - Parte 1
DESCARGAR EN PDF
Referencias a disposición
21 Reproducción porciNews A Latina Marzo 2024 | Placentación: Análisis del impacto en el peso fetal - Parte 1
OPERACIÓN SUPERVIVENCIA
NEONATAL:
REDUCCIÓN DE LA MORTALIDAD EN
SISTEMAS DE PARIDERAS ALTERNATIVAS

Mejorar la supervivencia neonatal es un objetivo permanente en la producción porcina, siendo el enfriamiento, la inanición y el aplastamiento por parte de la cerda las principales causas de mortalidad de lechones nacidos vivos.
Los aplastamientos se han combatido tradicionalmente mediante el uso generalizado de jaulas de parto que restringen los movimientos de la cerda, pero este tipo de instalaciones ocasionan problemas de bienestar a las cerdas. Entonces, ¿cuáles son las alternativas y cómo se puede maximizar la supervivencia de los lechones en los sistemas de alojamiento sin jaulas?
A medida que los ganaderos se plantean la transición hacia sistemas sin jaulas, hay que tomar decisiones clave para que ésta se haga con éxito existiendo distintos sistemas alternativos sobre los que se viene investigando desde hace muchos años. La mayoría de los sistemas disponibles en el mercado ofrecen alguna forma de con namiento temporal, pero estos sistemas requieren una gestión cuidadosa, especialmente en lo que respecta al cierre y la apertura de la jaula temporal. Por su parte, los sistemas sin con namiento bien diseñados permiten alcanzar tasas de supervivencia de lechones equivalentes a las de las jaulas de parto.
Las personas siguen siendo el factor que más contribuye a los resultados de Bienestar Animal, debiendo cuidarse la interacción humano-animal desde el principio, facilitando así el manejo durante el parto y la lactación con resultados positivos sobre el rendimiento y Bienestar Animal.
Emma Baxter
Investigadora experta en Comportamiento y Bienestar Animal, Scotland’s Rural College - SRUC
porciNews A Latina Marzo 2024 | Operación supervivencia neonatal. Reducción de la mortalidad en sistemas de parideras alternativas 22 manejo

Las tendencias en la mortalidad de lechones nacidos vivos muestran aumentos globales en la última década (Gráfica 1), situándose actualmente la media de la UE en el 14% (AHDB, 2021), mientras que los mortinatos representan un 6-8% adicional de mortalidad de lechones (Baxter y Edwards, 2018)

Gráfica 1. Tendencias en el porcentaje de lechones nacidos vivos (%LNV) y mortalidad de lechones nacidos vivos (%MLNV) en determinados países (EE.UU. y Dinamarca (DK)) y regiones (UE). Datos de InterPig, PigCHAMP y SEGES Innovation.
19,00 18,00 17,00 16,00 15,00 14 ,00 13,00 12,00 11,00 10,00 2010 2011 2012 2013 2014 2015 2016 2017 2018 2019 2020 2021 Año
o
entaje de le c h o n es
% ) %LNV
%MLNV
%LNV
%MLNV
EE
P
r c
(
UE
UE
DK
DK %LNV EE.UU. %MLNV
.UU.
porciNews A Latina Marzo 2024 | Operación supervivencia neonatal. Reducción de la mortalidad en sistemas de parideras alternativas 23 manejo
El reto de la mortalidad neonatal sin jaulas
Las principales causas de mortalidad de lechones nacidos vivos son:
El enfriamiento
La inanición
El aplastamiento por parte de la cerda
Los aplastamientos se han combatido tradicionalmente mediante el uso generalizado de jaulas de parto que restringen los movimientos de la cerda, creando así un mayor control sobre sus cambios de postura.
Las jaulas también facilitan un manejo relativamente sencillo a los ganaderos, incluida la calefacción selectiva y el acceso seguro para asistir a los lechones.
Sin embargo, este tipo de instalaciones ocasionan importantes problemas de bienestar a las cerdas, ya que restringen física y conductualmente su libertad de movimiento.
La exitosa campaña de la Iniciativa Ciudadana Europea (ICE) “End the Cage Age” contra los sistemas de jaulas para todas las especies ganaderas ha dado lugar a que la Comisión Europea presente una propuesta que podría prohibir su uso a partir del 2027, tras una evaluación de impacto científico (EFSA, 2022) y después de un período de transición adecuado.


porciNews A Latina Marzo 2024 | Operación supervivencia neonatal. Reducción de la mortalidad en sistemas de parideras alternativas 24 manejo
Entonces, ¿cuáles son las alternativas y cómo se puede maximizar la supervivencia de los lechones en los sistemas de alojamiento sin jaulas?

A medida que los ganaderos se plantean la transición hacia sistemas sin jaulas, hay que tomar decisiones clave para que ésta se haga con éxito (Baxter et al., 2022), existiendo una serie de sistemas alternativos de parideras y lactación sobre los que se viene investigando desde hace muchos años.
Sistemas de parideras con confinamiento temporal
La mayoría de los sistemas disponibles en el mercado ofrecen alguna forma de confinamiento temporal, variando en cuanto a su capacidad de mejorar el bienestar y rendimiento de los animales, incluidas las tasas de supervivencia de los lechones (Goumon et al., 2022; EFSA, 2022).
La elección de un sistema de jaulas temporales puede ser una opción atractiva para los productores, ya que les permite controlar a la cerda.
Sin embargo, estos sistemas requieren una gestión cuidadosa, especialmente en lo que respecta al cierre y apertura de la jaula temporal, ya que puede influir en el comportamiento de la cerda y afectar a la supervivencia de los lechones (revisado en Goumon et al., 2022).
porciNews A Latina Marzo 2024 | Operación supervivencia neonatal. Reducción de la mortalidad en sistemas de parideras alternativas 25 manejo
Sistemas de parideras sin confinamiento
Con los sistemas sin confinamiento bien diseñados (es decir, verdaderas parideras libres) se pueden alcanzar tasas de supervivencia de lechones equivalentes a las de las jaulas de parto, así como ventajas en términos de crecimiento y desarrollo de los lechones (Baxter y Edwards, 2021; Andersen y Ocepek, 2022).
Para ello, se requieren unas características de diseño específicas que fomenten un buen comportamiento maternal, incluida una ubicación óptima de la paridera, cerca de la fuente de calor suplementaria (nido para los lechones) y con fácil acceso desde el pasillo para que el personal pueda intervenir.

Independientemente del tipo de paridera elegido, un buen diseño debe considerar cuidadosamente la cantidad y calidad del espacio para maximizar el bienestar y rendimiento de los animales.
El factor humano como elemento clave
en la supervivencia neonatal
Mejorar la supervivencia de los lechones en cualquier sistema es un reto cuando los ganaderos tienen que gestionar la tendencia continua de criar camadas muy grandes, lo que ha exacerbado la mortalidad de los lechones (Gráfica 1)
Los lechones nacen con menor peso y cada vez hay más con crecimiento intrauterino restringido (Matheson et al., 2018) Así, un mayor número de lechones vulnerables y de bajo peso al nacimiento implica la necesidad de mayor intervención del personal para optimizar su supervivencia (Peltoniemi et al., 2021).
porciNews A Latina Marzo 2024 | Operación supervivencia neonatal. Reducción de la mortalidad en sistemas de parideras alternativas 26 manejo
Esto puede suponer un reto en cualquier entorno de parto, pero los sistemas alternativos que permiten a la cerda una mayor libertad de movimientos deben tener en cuenta características de diseño que ayuden a facilitar intervenciones humanas seguras al tiempo que se optimiza el bienestar de la cerda y sus lechones.
Las personas siguen siendo el factor que más contribuye a los resultados de Bienestar Animal, por lo que es importante que se desarrolle una relación humana positiva con las cerdas desde la fase de recría.
Este es un factor crítico que a menudo se pasa por alto, pero que facilita el manejo durante el parto y la lactación con resultados positivos sobre el rendimiento y Bienestar Animal.
Operación supervivencia neonatal: Reducción de la mortalidad en sistemas de parideras alternativas
DESCÁRGALO EN PDF
ACCEDER A BIBLIOGRAFÍA


porciNews A Latina Marzo 2024 | Operación supervivencia neonatal. Reducción de la mortalidad en sistemas de parideras alternativas 27 manejo
ARMADO Y CONSOLIDACIÓN DE EQUIPOS DE TRABAJO:
LA SOLUCIÓN A LA ROTACIÓN DE PERSONAL
Gastón Imola
Facilitador y Coach. Liderazgo en granjas porcinas.


Organismos unicelulares que tienen la capacidad de moverse se van de un lugar a otro, los cerdos con los que trabajas se van de un lugar a otro, los hijos se van de la casa de sus padres, los que están casados a veces se van, tú te vas de algunos lugares y por supuesto las personas que trabajan en tu granja también se van.
porciNews A Latina Marzo 2024 | Armado y consolidación de equipos de trabajo: La solución a la rotación de personal 28 recursos humanos
Este fenómeno se da en cualquier granja de cualquier lugar del mundo, es un proceso natural.
Pero cuando de manera periódica hay personas que eligen irse, y necesitas contratar nuevas, se genera alta rotación de personal, dificultades en la consolidación de equipos y tus pérdidas económicas se disparan.
Estamos preparados biológicamente para utilizar este mecanismo, los motivos pueden ser varios, aunque no tantos, si tuviera que reducirlo a uno diría que nos vamos buscando “estar mejor”.
“Ningunos de nosotros nos vamos de un lugar en el que queremos estar”
Construyamos y consolidemos espacios donde las personas quieran estar, principalmente tú.
La responsabilidad de construir estos espacios es del dueño del negocio y aquí necesitamos hacer una distinción.
El negocio es la producción de cerdos, pero el trabajo que te toca es otro ya que…
Las personas son el centro de la productividad, son los que gestionan:
Los recursos de las instalaciones,
La genética,
La nutrición y
La sanidad.
Todas estas tecnologías de insumos son mediadas por la tecnología humana
PRODUCCIÓN DE HUMANIDAD

“Tú no eres un productor de cerdos, tú gestionas personas que producen cerdos”
Dominio del liderazgo
Construcción de relaciones
Generación de rentabilidad
porciNews A Latina Marzo 2024 | Armado y consolidación de equipos de trabajo: La solución a la rotación de personal 29 recursos humanos

“Mejores personas, mejores empresas, mejores resultados”
En una granja de última generación las personas son el 6% de los costos que generan el 100% de los resultados.
Cuando se ponen a las personas en el centro y los procesos a su alrededor es cuando se captura una altísima rentabilidad económica y en calidad de vida para toda la empresa.
LIDERAZGO CONSTRUCTOR DE RELACIONES
El liderazgo juega en esta consolidación un papel definitivo, es un liderazgo que funciona desde el ámbito de la Responsabilidad (habilidad de dar respuesta) y no desde la Culpabilidad (echar culpas a las circunstancias o las personas).
Los líderes que formamos se detienen, analizan lo que pasa y solo se preguntan una cosa:
¿Qué necesito hacer ante estas circunstancias?
El liderazgo que proponemos se manifiesta en una “vida de acciones deliberadas” sin culpar a las circunstancias sino eligiendo las acciones necesarias para los resultados buscados.
porciNews A Latina Marzo 2024 | Armado y consolidación de equipos de trabajo: La solución a la rotación de personal 30 recursos humanos
Pasos por seguir para que las personas quieran quedarse en la granja
Aquellos que están al frente de estos grupos de personas, han sido muy buenos en lo operativo, pero nunca, nadie les ha brindado los conocimientos ni el entrenamiento necesario para gestionar personas, reunidas en un sistema social único y particular que es ese equipo de trabajo
02 04 Productor de alimentos
Conciencia que produces un alimento complejo y completo para la humanidad, necesita de altos estándares de calidad y e ciencia en los procesos y mano de obra cali cada.
Buenos salarios, altos premios por productividad y no faltar.
Premios en tiempo, en dinero, en especie.
Instalaciones (comedor, baños, duchas, salas de capacitación) cómodas, de alta calidad y funcionalidad, que tengan la ropa, elementos de protección y herramientas, alimentos, hidratación y descanso en las horas de trabajo.
01 03
Mejorar las condiciones
Cuidar a l a s p e
Y ellas cuidarán de tu granja, la reciprocidad es el mecanismo que tienes que poner en marcha y aprovechar. Atención a todas sus necesidades.

Mi tarea es formar líderes que construyan relaciones, consoliden equipos de trabajo y que sean los productores de humanidad.
tneyramroF
sanosr
r e n a r l í dereshumanos
porciNews A Latina Marzo 2024 | Armado y consolidación de equipos de trabajo: La solución a la rotación de personal 31 recursos humanos
LA MOTIVACIÓN PARA QUEDARSE EN LA GRANJA
La motivación puede generarse mediante una acción puntual como una charla, pero aquí te quiero hablar de una motivación sostenida en el tiempo.

Edward L. Deci y Richard Ryan en 1985 proponen la Teoría de la autodeterminación y dicen que la motivación humana depende de cubrir tres necesidades psicológicas básicas:
Las personas crecen y están motivadas cuando se sienten competentes y hábiles para hacer un trabajo.
Solución: Capacitación técnica
Las personas encuentran atractivo y se sienten motivadas cuando en su trabajo tienen espacios de libertad para actuar de manera autónoma teniendo cosas que decidir todos los días a su estilo.
TEORIA DE LA AUTODETERMINACIÓN
Solución: Delegación
Sanas relaciones
Tener alta rotación de personal, no poder consolidar los equipos de trabajo seguirá siendo un problema mientras no te ocupes del desarrollo de las personas, lo técnico y en lo humano, aquí está el bien que puedes hacer y el dinero que puedes ganar. En un solo lugar y en tus manos.
Un lugar en el cual se ha construido una red de relaciones saludables, donde encuentras compañeros que aprecias y te aprecian, donde has aprendido que significa comprometerte, comunicarte, complementarte y coordinar trabajos en un clima de confianza se transforma en el lugar en el cuál quiero estar.
Solución: Formación en liderazgo y Competencias Genéricas.
Armado y consolidación de equipos de trabajo: la solución a la rotación
DESCÁRGALO EN PDF
de personal
Autonomía
Competencia
porciNews A Latina Marzo 2024 | Armado y consolidación de equipos de trabajo: La solución a la rotación de personal 32 recursos humanos

LA PROTECCIÓN MÁS EFICAZ Y SEGURA

EFICACIA PROBADA
FRENTE A LA DISENTERÍA PORCINA

EFICAZ A MUY BAJAS DOSIS
VERSATILIDAD EN SU USO
RESPETUOSO CON LOS MATERIALES Y SUPERFICIES



DESINFECTANTE OHSAS 18001
NUEVAS FORMULACIONES EN DILUYENTES ESPERMÁTICOS: VARIACIONES EN LA CONCENTRACIÓN DE AZÚCARES Y USO DE PÉPTIDOS PARA COMBATIR LAS RESISTENCIAS
ANTIMICROBIANAS

Si hablamos de reproducción animal, mantener la calidad seminal a lo largo del tiempo es crítico para el éxito de la reproducción.
Cuando diluimos el esperma en una formulación específica para protegerlo durante el transporte y almacenamiento, es esencial que se conserve la capacidad fecundante de los espermatozoides.
Por ello, la calidad del diluyente espermático empleado tendrá un impacto directo en los resultados de fertilidad.
Ante ese desafío, en el área agroalimentaria de ARQUIMEA, en colaboración con el CSIC, hemos estado trabajando en diferentes proyectos de investigación con el objetivo de mejorar las fórmulas clásicas de nuestros diluyentes, analizándolas mediante tecnologías punteras que no existían cuando fueron formuladas o no eran tan accesibles.
Pablo Fernández Veterinario responsable de desarrollo de producto, ARQUIMEA
publirreportaje 34 publireportaje porciNews A Latina Marzo 2024 | Nuevas formulaciones en diluyentes espermáticos: variaciones en la concentración de azúcares y uso de péptidos para combatir las resistencias...
Si bien, parámetros como el pH o la osmolaridad se siguen teniendo en cuenta, ahora podemos incluir análisis adicionales como, por ejemplo:
Medición de la vitalidad mediante fluorescencia gracias a equipos completamente automatizados.
Disponibilidad de parámetros cinéticos más precisos y objetivos.
El análisis de resultados del metabolismo celular en tiempo real.
LA
ACCESIBILIDAD A TECNOLOGÍAS DE ANÁLISIS DEL METABOLISMO
CELULAR PERMITE MEJORAR LAS FORMULACIONES DE NUEVOS
DILUYENTES
La tecnología de análisis del metabolismo celular ha experimentado grandes avances recientemente, volviéndose además mucho más accesible y permitiendo la detección en tiempo real de cambios en el consumo de energía celular.
Gracias a esta tecnología, ahora somos capaces de:
Caracterizar el metabolismo espermático.
Cuantificar la energía consumida por los espermatozoides, tanto por fosforilación oxidativa, como por glicólisis.
Observar cómo se comportan los espermatozoides en situaciones de estrés, como la falta de energía o la acumulación de metabolitos tóxicos en el medio.
VALORACIÓN DE DIFERENTES
DILUYENTES CON VARIACIONES EN COMPOSICIÓN Y CONCENTRACIÓN DE AZÚCARES
Por medio de estas tecnologías de vanguardia, ARQUIMEA y el CSIC llevaron a cabo una exhaustiva caracterización del metabolismo espermático.
Con el objetivo de conservar la capacidad fecundante de los espermatozoides durante más tiempo, evaluaron diversos diluyentes con variaciones en composición y concentración de azucares.
Estos componentes, más allá de su función como fuente de energía esencial durante la conservación, desempeñan un papel crucial en el mantenimiento de la presión osmótica del medio, un factor determinante para preservar la integridad de la membrana celular.

publirreportaje 35 publireportaje porciNews A Latina Marzo 2024 | Nuevas formulaciones en diluyentes espermáticos: variaciones en la concentración de azúcares y uso de péptidos para combatir las resistencias...
Los resultados del proyecto no solo proporcionaron mucha información a la hora de ajustar la concentración de los diferentes componentes del diluyente, sino que sometieron esas nuevas formulaciones a otra batería de pruebas adicionales para evaluar su eficacia:
Medición de motilidad y parámetros cinéticos: analizado con ISAS Boar, el sistema CASA de ARQUIMEA.
Valoración de la integridad del acrosoma: mediante muestras fijadas en glutaraldehído-cacodilato y observación en contraste de fases.
Potencial de membrana: medido mediante tinción con JC-1.
Medición de vitalidad mediante calidad de membrana (una de las que consideramos entre las más importantes): calculado usando doble tinción fluorescente en el sistema de análisis automático SQS2 de ARQUIMEA.
Se llevaron a cabo todas estas comprobaciones durante un periodo de 8 días, que es la duración máxima contemplada para el empleo del diluyente.
Aquellas fórmulas que arrojaron los mejores resultados se sometieron a pruebas de campo con inseminaciones.
A partir de los resultados obtenidos, tanto en las pruebas in vitro como en las pruebas de campo, se elaboró un índice para cada diluyente teniendo en cuenta todas estas variables.
RESULTADOS DEL ESTUDIO: UNA CORRELACIÓN MUY ALTA ENTRE LA CALIDAD DE LA MEMBRANA Y LOS RESULTADOS DE FERTILIDAD
En determinados escenarios, la ponderación de los parámetros varía en función del uso previsto del diluyente, ya sea para períodos de corta, media o larga duración.
Esta adaptabilidad refleja la consideración cuidadosa de las características específicas necesarias para cada aplicación.
En otros casos, la asignación de peso a un parámetro en la fórmula puede basarse no solo en la duración del almacenamiento, sino también en correlaciones específicas identificadas con resultados observados in vivo.
ARQUIMEA, junto con CSIC, observó que la calidad de la membrana y la integridad del acrosoma destacaban como los factores más cruciales para obtener mejores resultados de fertilidad. Por ello, a la hora de formular sus diluyentes, desarrollaron una fórmula que priorizara la vitalidad de la membrana y la integridad del acrosoma tras la dilución frente a otros aspectos.
Con estos resultados, la tecnológica ARQUIMEA reformuló ACROMAX, su diluyente de acción larga que se basaba en esta premisa fundamental.
Así es como nació ACROMAX PLUS, un diluyente capaz de mantener la integridad de la membrana durante más tiempo y, por tanto, poder obtener mejores resultados de fertilidad.
publirreportaje 36 publireportaje porciNews A Latina Marzo 2024 | Nuevas formulaciones en diluyentes espermáticos: variaciones en la concentración de azúcares y uso de péptidos para combatir las resistencias...
RESISTENCIAS ANTIMICROBIANAS:
EL RETO FUTURO DE LOS DILUYENTES
Un componente importante en la formulación de los diluyentes espermáticos es el antibiótico, cuya función es prevenir proliferación de microorganismos patógenos en la mezcla.
Según datos del PRAN (Plan Nacional frente a la Resistencia a los Antibióticos), entre el 2014 y 2019 se ha producido un descenso del 59% en el uso de antibióticos en veterinaria.
En el marco de la estrategia One Health para la sanidad animal, con su programa Reduce, se ha propuesto continuar reduciendo el consumo de antibióticos veterinarios.
Para combatir los fenómenos de resistencias indeseadas a los antibióticos en los animales y su posible transmisión a los humanos, en la actualidad, el gran reto supone buscar alternativas igual de eficaces al uso de los antibióticos tradicionales en la composición de los diluyentes de semen.

Por ello, ARQUIMEA emprendió un segundo proyecto de investigación con el CSIC con el propósito de desarrollar un nuevo tipo de diluyente seminal porcino que prescinda del antibiótico convencional, pero que mantenga sus propiedades antimicrobianas.

Apostaron por el análisis de eficacia de formulaciones de diluyentes basados en el uso de péptidos antimicrobianos (AMP) aniónicos y catiónicos y otros compuestos potenciadores.
Estos péptidos antimicrobianos (AMP) son proteínas de origen natural (obtenidos de plantas, insectos y mamíferos) o sintetizados artificialmente, caracterizados por sus propiedades antibióticas y antimicrobianas.
A lo largo del proyecto:
Se estudió la posible influencia de los AMPs en los tiempos de conservación, vitalidad y motilidad de los espermatozoides.
Se determinó el impacto sobre el poder fecundante del esperma.

Imagen 1. Crecimientos microbianos que luego se utilizaron para identificar los microorganismos. Imagen 2. Producción de biomasa y recogida en cabina de las bacterias.
publirreportaje 37 publireportaje porciNews A Latina Marzo 2024 | Nuevas formulaciones en diluyentes espermáticos: variaciones en la concentración de azúcares y uso de péptidos para combatir las resistencias...

Imagen 3. Cribaje mediante antibiogramas para ver el efecto de la sustancia.
RESULTADOS DEL ESTUDIO: EL USO DE PÉPTIDOS PROPORCIONA UNA EFICACIA TAN ALTA COMO LAS FÓRMULAS CON ANTIBIÓTICOS TRADICIONALES
Los resultados, después de más de dos años de investigación probando diferentes péptidos, concentraciones y potenciadores, han resultado muy positivos.

La fórmula elegida tuvo una eficacia tan alta como las fórmulas actuales con antibióticos tradicionales a la hora de frenar el crecimiento de microorganismos, incluidos aquellos considerados de mayor peligro para la conservación del semen.
El siguiente objetivo de ARQUIMEA para este año consiste en producir y purificar, de forma propia, los AMPs de mayor interés para, después, incorporar a su catálogo un nuevo diluyente que no genere resistencias.
LA CONSTANTE INVERSIÓN EN I+D+i PARA NUEVAS FORMULACIONES DE DILUYENTE PERMITE MEJORAR LOS RESULTADOS DE FERTILIDAD Y AFRONTAR LOS NUEVOS RETOS DEL SECTOR
Con más de 20 años de experiencia en la fabricación de diluyentes, ARQUIMEA invierte cada año en I+D+i en búsqueda de nuevas formulaciones que den respuesta a los retos del sector.
Su deseo de mejorar los resultados de fertilidad ha generado:
Nuevas composiciones y combinaciones de azúcares.
Nuevos diluyentes sin antibiótico.
Novedosos métodos de congelación seminal.
Compuestos experimentales que pueden actuar como crioprotectores para trabajar con semen congelado.

Todo ello refleja el compromiso continuo de ARQUIMEA con la innovación en la optimización constante de la eficacia de sus productos en el campo de la reproducción animal.
Nuevas formulaciones en diluyentes espermáticos: variaciones en la concentración de azúcares y uso de péptidos para combatir las resistencias antimicrobianas DESCÁRGALO EN PDF
publirreportaje 38 publireportaje porciNews A Latina Marzo 2024 | Nuevas formulaciones en diluyentes espermáticos: variaciones en la concentración de azúcares y uso de péptidos para combatir las resistencias...



ABORDANDO EL DESAFÍO DEL ÓPTIMO RENDIMIENTO DE LAS CERDAS LACTANTES
Traducido y adaptado de Farmer C. Achieving optimal sow performance, still an ongoing challenge in 2022 Anim Front. 2022 Dec 14;12(6):53-55.
doi: 10.1093/af/vfac064. PMID: 36530507; PMCID: PMC9749810.
Hace tres décadas, la productividad porcina enfrentaba desafíos significativos. Un 20% de los lechones morían antes del destete, y las cerdas no producían suficiente leche para el óptimo crecimiento de los supervivientes.
Actualmente, este dilema persiste, con una tasa de mortalidad pre destete del 15%. ACCEDER


porciNews A Latina Marzo 2024 | Abordando el desafío del óptimo rendimiento de las cerdas lactantes 40 investigación



Los lechones mueren durante el proceso de parto o al comienzo de la lactancia. El problema de la producción inadecuada de leche de las cerdas aún persiste porque si bien se han mejorado las prácticas de manejo y la nutrición, la presión de selección genética para aumentar el tamaño de la camada ha llevado al desarrollo de nuevas líneas de cerdas hiperprolíficas.
Por lo tanto, los 10 lechones nacidos vivos por camada que se veían generalmente hace un tiempo ahora son fácilmente de 16 a 18 lechones.
La cerda es una gran productora de leche; por kilogramo de peso corporal, puede producir más leche que una vaca lechera. Sin embargo, con el aumento del tamaño de la camada, cada lechón dispone de menos leche.
La cantidad total de calostro producido por las cerdas no está relacionada con el tamaño de su camada, por lo que la ingesta de calostro por parte de los lechones recién nacidos también es inadecuada en muchos casos, lo que conduce a una menor supervivencia y un crecimiento deficiente.
Disminución de la mortalidad de los lechones antes del destete
Las dos causas más importantes de muerte:
Existen muchos factores predisponentes que conducen a estos problemas (Farmer y Edwards, 2022)
Los lechones recién nacidos son los más vulnerables por varias razones: lechones nacidos muertos y aplastamiento por parte de la cerda.


Nacen con baja reserva de energía (1% a 2% de grasa en canal)




Poseen una tasa metabólica baja




No tienen protección inmunológica



porciNews A Latina Marzo 2024 | Abordando el desafío del óptimo rendimiento de las cerdas lactantes 41 investigación

El glucógeno hepático y muscular son importantes reservas de energía para los lechones recién nacidos, pero se agotan poco después del nacimiento.
Además, estos experimentan un shock térmico al nacer debido a la caída repentina de 15 a 20 °C en su ambiente térmico, y debido a su bajo suministro de energía y su inmadurez metabólica, deben depender de fuentes externas de calor para la termorregulación (Farmer y Edwards, 2022).
Por tanto, el calostro es esencial para proporcionar a los lechones una fuente de energía e inmunidad pasiva, para activar la producción de calor y para suministrar diversos factores de crecimiento y compuestos bioactivos.
Un lechón recién nacido con un peso corporal promedio (1,4 kg) debe ingerir un mínimo de 250 g de calostro para sobrevivir y crecer, y aproximadamente un tercio de las cerdas no producen suficiente calostro para proporcionar esta cantidad crítica a cada uno de sus lechones con el tamaño de camada actual. (Quesnel y Farmer, 2019).
250 g de calostro
La producción de calostro es muy variable entre cerdas y es difícil de aumentar. Además, faltan estudios sobre los mecanismos que controlan la calostrogénesis, probablemente debido a la dificultad para medir el rendimiento de calostro en las cerdas.
No obstante, se obtuvieron hallazgos útiles y se demostró que la inducción del parto con el uso de prostaglandinas reduce la producción de calostro si se realiza demasiado temprano en la gestación. Por otro lado, la disponibilidad de calostro para los lechones se puede prolongar con una inyección de una dosis muy alta de oxitocina administrada 12 h después del inicio del parto (Farmer y Edwards, 2022).
La nutrición al final de la gestación tiene un mayor impacto en la composición del calostro que en su cantidad.
De hecho, el contenido de ácidos grasos del calostro depende en gran medida de la cantidad de lípidos proporcionados en la dieta de la cerda, mientras que el perfil de ácidos grasos del calostro está influenciado en gran medida por el tipo de lípido que se alimenta.

porciNews A Latina Marzo 2024 | Abordando el desafío del óptimo rendimiento de las cerdas lactantes 42 investigación
Además, varios ingredientes (como aceites de pescado, prebióticos y probióticos) parecen tener efectos inmunomoduladores que podrían aumentar las concentraciones de inmunoglobulinas calostrales cuando se administran durante las últimas semanas de gestación (Quesnel y Farmer, 2019).

Recientemente se prestó especial atención a las prácticas de alimentación durante el período de transición entre la gestación y la lactancia.
Este período de transición generalmente se define como una duración de 7 a 10 días antes del parto y de 3 a 5 días posparto (Theil et al., 2022) y es muy importante porque es cuando ocurre la mayoría de las muertes de lechones.
La nutrición durante este período crítico puede afectar en gran medida el crecimiento fetal, el desarrollo mamario, el parto y la colostrogénesis.
Alrededor del parto, la cerda a menudo carece de reservas de energía para satisfacer las demandas de construcción del nido, contracciones uterinas y producción de calostro, y un estado energético tan inadecuado puede prolongar el proceso de parto, aumentando así la tasa de muertes fetales.
Los mortinatos generalmente representan del 30% al 40% de todas las mortalidades antes del destete y la causa principal es la falta de oxígeno durante el proceso del parto.

Estas muertes son más frecuentes en las cerdas hiperprolíficas modernas debido a que su proceso de parto es más prolongado, lo que constituye un importante factor de riesgo (Farmer y Edwards, 2022).
porciNews A Latina Marzo 2024 | Abordando el desafío del óptimo rendimiento de las cerdas lactantes 43 investigación
Un hallazgo importante con respecto a la alimentación de transición es que las cerdas deben recibir un suministro de alimento adecuado, al menos tres comidas diarias o energía suplementaria antes del parto para ayudar a aliviar este problema de muerte fetal (Theil et al., 2022).
Alimentar con dietas con un mayor contenido de ciertos tipos de fibra (por ejemplo, pulpa de remolacha azucarera) también es beneficioso para reducir el riesgo de estreñimiento y proporcionar un suministro de energía más constante después de las comidas, ayudando así a acortar el proceso del parto.
Por otro lado, el peso de los lechones al nacer parece responder sólo ligeramente a la nutrición materna de las primerizas gestantes.
En términos de producción de calostro, la ingesta de energía y lisina parece desempeñar un papel importante, y la alimentación con dietas ricas en fibra puede mejorar potencialmente tanto el rendimiento como la composición del calostro.


Sin embargo, las respuestas son variables según la fuente de fibra (Theil et al., 2022).
Es importante el hecho de que la alta incidencia de mortalidad pre-destete no sólo está asociada con el bajo peso al nacer de los lechones, sino también con la presencia de lechones con crecimiento intrauterino restringido (RCIU).
Estos lechones RCIU se observan comúnmente en camadas de cerdas hiperprolíficas como resultado de una transferencia placentaria insuficiente de nutrientes (Farmer y Edwards, 2022).
La vitalidad de cada uno de los lechones, combinada con el comportamiento de su madre y las condiciones adecuadas de alojamiento, determinarán su supervivencia.
Por lo tanto, independientemente de la estrategia nutricional utilizada al final de la gestación, brindar asistencia a los lechones después del nacimiento puede aumentar sus posibilidades de supervivencia.
porciNews A Latina Marzo 2024 | Abordando el desafío del óptimo rendimiento de las cerdas lactantes 44 investigación
Se pueden utilizar varios enfoques, como:
01 02 03
04
05 optimizar el entorno de parto
supervisar el parto y ayudar a los lechones recién nacidos
utilizar técnicas de crianza cruzada
proporcionar cerdas nodrizas
proporcionar leche arti cial
Aumento de la producción de leche de las cerdas
La producción de leche de la cerda se ve afectada por numerosos factores
relacionados con la cerda (genética, raza, parto, tamaño de camada, etapa de lactación)
y también por factores externos (fotoperiodo, temperatura, estrés, hormonas, nutrición).
Los requerimientos de nutrientes de las cerdas lactantes han sido bien establecidos, pero el problema reside principalmente en lograr que la cerda consuma suficiente alimento para obtener estos nutrientes.
Así era hace 30 años y sigue siendo así hoy, sobre todo teniendo en cuenta que la drástica mejora en el rendimiento reproductivo de las cerdas lograda a lo largo de los años ha llevado a mayores necesidades nutricionales.
Por lo tanto, cualquier medio para aumentar el consumo de alimento de las cerdas durante la lactancia debería ser beneficioso en términos de producción de leche y crecimiento de los lechones.
Un aspecto que se pasaba por alto en el pasado pero que ahora recibe más atención es el desarrollo mamario.
De hecho, el número de células sintetizadoras de leche presentes en el tejido mamario al inicio de la lactancia tiene un gran impacto en la cantidad de leche producida.
Sin embargo, se desconocen las condiciones óptimas necesarias para favorecer el máximo desarrollo mamario

porciNews A Latina Marzo 2024 | Abordando el desafío del óptimo rendimiento de las cerdas lactantes 45 investigación
El estado hormonal, la nutrición y el manejo tienen un impacto en el grado de desarrollo mamario (Farmer, 2013), que ocurre en tres etapas específicas de la vida de la cerda:

La hormona clave, pero no la única, implicada en la mamogénesis es la prolactina.


El papel esencial de la prolactina para el desarrollo mamario al final de la gestación y durante la lactancia se demostró mediante estudios de inhibición clásicos (Farmer, 2022).

desde los 90 días de edad hasta la pubertad
desde el día 90 de gestación hasta el parto 01 03 02




durante la lactancia
Proporcionar una fuente exógena de prolactina a cerdas primerizas en crecimiento en la fase prepuberal crítica aumentó la deposición de tejido parenquimatoso mamario (donde se sintetiza la leche) en un 116 %, mientras que la inyección de prolactina durante la lactancia no tuvo ningún efecto sobre el desarrollo mamario (Farmer, 2013).
Sin embargo, cuando se utilizó un antagonista de la dopamina durante la lactancia para aumentar la síntesis de prolactina por parte de la cerda, la producción de leche mejoró (Farmer, 2022).
porciNews A Latina Marzo 2024 | Abordando el desafío del óptimo rendimiento de las cerdas lactantes 46 investigación


El aumento de las concentraciones circulantes del factor de crecimiento IGF-1 (factor de crecimiento similar a la insulina-1) mediante inyecciones de somatotropina desde los días 90 al 110 de gestación provocó un aumento del 22 % en la masa de tejido parenquimatoso mamario (Theil et al., 2022).
Por lo tanto, una vía de investigación importante sería desarrollar estrategias de alimentación que podrían conducir a un aumento del IGF durante la última etapa de la gestación
En términos de nutrición, no es aconsejable la restricción alimentaria de las primerizas en crecimiento desde los 90 días de edad hasta la pubertad porque reducirá el desarrollo mamario (Farmer, 2018).
Sin embargo, resultados recientes sugieren que sólo una reducción drástica en el consumo de alimento (de 2,88 a 2,11 kg/d de una dieta que contenga 13,8 MJ EM) afectará negativamente la producción futura de leche.
Durante la última etapa de la gestación, la sobrealimentación energética (44 MJ de EM/día) afectará negativamente el desarrollo mamario, y esto probablemente esté relacionado con la condición corporal porque las primerizas obesas (36 mm de grasa dorsal) tienen un desarrollo mamario más pobre que las primerizas con 25 mm de grasa dorsal.
Además, las primerizas que son demasiado delgadas (16 mm de grasa dorsal o menos) tienen un desarrollo mamario peor que las primerizas con 17 a 26 mm de grasa dorsal (Farmer, 2018).
Aunque se realizaron muchos estudios sobre los requerimientos de aminoácidos de las cerdas gestantes, se necesita más investigación.
De hecho, hallazgos recientes demostraron que aumentar la ingesta de lisina en un 40% por encima de las recomendaciones actuales a partir del día 90 de gestación, al incluir más harina de soja en la dieta, aumentó la masa de tejido parenquimatoso mamario en un 42%.
porciNews A Latina Marzo 2024 | Abordando el desafío del óptimo rendimiento de las cerdas lactantes 47 investigación
Estos hallazgos indican que las recomendaciones actuales de alimentación con lisina están subestimadas para las primerizas de gestación tardía.
Sin embargo, dado que la harina de soja también contiene aminoácidos distintos de la lisina y tiene un alto contenido de proteínas, es fundamental determinar si este efecto beneficioso se debió específicamente a una mayor ingesta de lisina.

Una práctica de manejo importante en cerdas de primer parto que afectará el desarrollo mamario y la producción de leche en el segundo parto es garantizar que todos los pezones sean utilizados.
El estímulo de succión por parte de los lechones es el factor clave necesario para mantener la lactancia (Farmer, 2019).
Las cerdas primíparas que tienen una mala condición corporal al momento del parto pueden perjudicar su rendimiento reproductivo a largo plazo si producen demasiada leche en la primera lactancia.
Por lo tanto, los productores pueden reducir el tamaño de la camada de dichos animales
Sin embargo, ahora se sabe que un pezón que no es succionado en la primera lactancia estará menos desarrollado y producirá menos leche en la segunda lactancia.
También se sabe que amamantar un pezón durante las primeras 48 horas después del parto en la primera lactancia es adecuado para garantizar que la producción de leche de ese pezón no se vea impedida en la segunda lactancia (Farmer, 2019).

Por lo tanto, se puede realizar adopción cruzada para disminuir el tamaño de la camada de cerdas primíparas muy delgadas, pero solo al tercer día posparto.
3 porciNews A Latina Marzo 2024 | Abordando el desafío del óptimo rendimiento de las cerdas lactantes 48 investigación
CONCLUSIÓN

Se han realizado muchos avances científicos en cuanto al manejo y nutrición de las cerdas con el objetivo de maximizar su rendimiento en lactancia y se puede pensar que no es necesario realizar más investigaciones, pero definitivamente no es así.
Actualmente, las cerdas todavía limitan la tasa de crecimiento de sus lechones debido a una producción inadecuada de leche y esto está relacionado en parte con el desarrollo de nuevas líneas de cerdas hiperprolíficas.
Por lo tanto, se debe seguir haciendo hincapié en la investigación en áreas como el desarrollo de estrategias para mejorar el desarrollo mamario, definir la alimentación óptima de las primerizas de reemplazo, ajustar los requisitos nutricionales al final de la gestación y establecer las mejores prácticas de alimentación de transición.
También es necesario prestar especial atención al proceso de calostrogénesis para aumentar la ingesta de calostro por parte de los lechones recién nacidos.
En los últimos años han surgido muchos nuevos campos de investigación en la ciencia animal. Se presta más atención a aspectos importantes como el impacto medioambiental y la sostenibilidad.
Sin embargo, no hay que olvidar que la productividad sigue siendo una preocupación importante en algunas especies, como las cerdas lactantes.

Abordando el desafío del óptimo rendimiento de las cerdas lactantes
DESCÁRGALO EN PDF
BIBLIOGRAFÍA
porciNews A Latina Marzo 2024 | Abordando el desafío del óptimo rendimiento de las cerdas lactantes 49 investigación

PROP 12: EXIGENCIAS
NORMATIVAS PARA HABILITAR LA EXPORTACIÓN DE CARNE DE CERDO A CALIFORNIA
M. Verónica Jiménez G. MV MSc Etología y Bienestar Animal
Muchos se preguntan
¿Cómo cambiarán los requisitos de esta normativa acerca del espacio para la cría de cerdos?
¿Qué implicaciones tendrá esto en términos de costos, infraestructura y prácticas de cría?


50 bienestar porciNews A Latina Marzo 2024 | Prop 12: Exigencias normativas para habilitar la exportación de carne de cerdo a California


Desde el 2008 que se viene hablando acerca de las mejoras en cuanto al alojamiento de animales dentro de sistemas productivos en el estado de California.
El 6 de noviembre de 2018, fue aprobada la Prop 12 por los votantes del Estado.
En donde se modificaron los requisitos del Capítulo 13.8, secciones 25990 a 25994, del Código de Salud y Seguridad (HSC), Propuesta 2 (2008), añadiendo requisitos de alojamiento específicamente acerca del espacio mínimo utilizable por hembra en gestación y maternidad, cuyo objetivo es el de tener la capacidad de libertad de movimiento, y expresión de conductas propias de la especie como el anidamiento en cerdas prontas al parto, logrando con esto, una mejora significativa en la calidad de vida.
Esta es una medida histórica diseñada para mejorar las condiciones de vida de los animales de granja en el estado de California, pero se presume que varios otros estados van a promover leyes similares.
Esta legislación ha sido objeto de intensos debates y ha generado un impacto significativo en la industria productiva y, más importante aún, sobre en el bienestar de los animales.
En este artículo, exploraremos los aspectos clave de la Proposición 12 y analizaremos cómo ha beneficiado a los animales y a la industria.
51 bienestar porciNews A Latina Marzo 2024 | Prop 12: Exigencias normativas para habilitar la exportación de carne de cerdo a California 2008
¿QUÉ ES LA PROP 12?

Normas más estrictas en cuanto al alojamiento, documentación y registros para la Cría de gallinas ponedoras, cerdos y terneros, garantizando que tengan suficiente espacio para moverse y realizar comportamientos naturales.
Esta ley específicamente para cerdos aplica solamente para Sitios 1, concretamente en hembras de gestación y crianza, y exige espacio mínimo (24 pies cuadrados o 2,23 m2) para cada hembra que sea mantenida en estas etapas con fines reproductivos y que tenga seis (6) o más meses de edad, o esté preñada.
FECHA LÍMITE
Todo aquel productor o distribuidor que quiera vender carne de cerdo al Estado de California debe estar certificado por el CDFA (California Department of Food and Agriculture) o un agente certificador tercero para el 1 de enero 2024 con el objetivo de asegurar que las hembras han sido criadas siguiendo las pautas de esta normativa.
El consumidor de hoy en día no conoce como son criados los animales en los sistemas productivos, de hecho, muchos se informan a través de redes sociales o documentales que muchas veces no demuestran realmente las condiciones en que se crían.

52 bienestar porciNews A Latina Marzo 2024 | Prop 12: Exigencias normativas para habilitar la exportación de carne de cerdo a California
ÍTEMS PARA CONSIDERAR


ANIMALES AMPARADOS
Toda hembra que sea mantenida con fines reproductivos y que tenga seis (6) o más meses de edad, o esté preñada.
Fuente: CDFA. 01
ETAPA PRODUCTIVA
Todo aquel lugar en donde estén alojados, mantenidos, producidos, procesados, sean manejados, o transportados aquellas cerdas amparadas bajo esta ley, es decir, Sitio 1, gestación y maternidad.
ESPACIO
Todos los recintos deben permitir que las cerdas reproductoras se puedan acostar, levantar, extender completamente las extremidades y girar sobre sí mismas con total libertad.
Todos los recintos proporcionan un mínimo de 24 pies cuadrados o 2.23 m2 de espacio útil por cada cerda reproductora. 3 CCR sección 1326.2(a) y 1326.2(b)(1).
Por ejemplo, para gestación, el CDFA creo una Guía para el alojamiento de las hembras. Por ley no se permite el alojamiento en jaula individual, por lo que cerdas gestantes alojadas como ilustra el Anexo A o B, NO cumplirían con la Prop 12 (figura 1).
En cambio, en el Anexo C, Sí cumpliría, ya que tiene el espacio mínimo solicitado y además, la hembra puede girar libremente sin tocar la instalación y/u otra cerda.
DESCARGAR GUÍA DEL CDFA

Anexo A - C: Sistemas de Recinto Individual Anexo
C
A Anexo B Anexo
Figura 1. Sistemas de recinto individual para cerdas.
porciNews A Latina Marzo 2024 | Prop 12: Exigencias normativas para habilitar la exportación de carne de cerdo a California 53 bienestar
02 03
PRODUCTORES
Dirigido a quienes realizan cría comercial para producir carne de cerdo a partir de la cerda reproductora o su descendencia inmediata para el consumo humano.
Va a involucrar ciertos aumentos de costos de producción si no se cumplen los requisitos de alojamiento.
INVERSIÓN


La ley exige espacio mínimo utilizable de suelo por hembra, por lo que aquellos productores que voluntariamente quieran exportar carne de cerdo a california deben realizar modificaciones para cumplir con los requisitos de espacio, esto incluye la expansión de sus instalaciones y /o la remodelación de las instalaciones actuales o, disminuir la densidad por corral.

Dentro de las inversiones que el productor debe considerar podríamos destacar la expansión de corrales y la implementación de cambios en las prácticas de crianza, como por ejemplo la gestación en corral, ya que no se permite alojar a las hembras en recintos no conformes mas de 6 horas en un día y no mas de 24 horas en 30 días.
Además, otro costo a considerar es el de las certificaciones, oficialmente los únicos autorizados para realizar las auditorías del cumplimiento es el CDFA y los agentes certificadores aprobados por el CDFA
ACCEDER
04 05
54 bienestar porciNews A Latina Marzo 2024 | Prop 12: Exigencias normativas para habilitar la exportación de carne de cerdo a California
REGISTROS DE TRANSACCIONES DE COMPRA Y/O VENTA REGISTROS
INVENTARIO DE LOS ANIMALES
Cantidad de cerdos reproductores alojados en cada registro (debe incluir fechas alojamiento, movimiento y producción).
Cantidad de cerdos reproductores producidos o procesados de cada instalación o unidad de granja.
Número de recintos para cerdos reproductores de cada instalación o unidad de granja, el tamaño y la superficie útil de cada recinto.
Relativos a la producción, procesamiento, manipulación, preparación, alojamientoalmacenamiento, transporte o venta de todos aquellos cerdos reproductores, vendidos, destinados a la venta en el estado de California o identificados o representados como conformes con los requisitos.
Se deben mantener registros lo suficientemente detallados como para documentar que las cerdas reproductoras fueron confinadas en cumplimiento de los requisitos.
“Se requiere que los registros estén disponibles durante no menos de dos (2) años después de su creación”
DOCUMENTOS
Mapa de las instalaciones actualizado que enseñe las dimensiones de los alojamientos de los animales amparados bajo la ley.
Segregación
Para aquellos que sólo van a certificar una parte de su sistema productivo (algunos sitios 1) se puede, pero se debe demostrar segregación.
Incluir las prácticas de gestión, las barreras físicas y los procedimientos operativos estandarizados establecidos para evitar la mezcla de cerdos reproductores conformes y su descendencia inmediata. 3 CCR sección 1326



55 bienestar porciNews A Latina Marzo 2024 | Prop 12: Exigencias normativas para habilitar la exportación de carne de cerdo a California
EXCEPCIONES DE LA LEY
Esta ley no se aplicará:
Durante períodos temporales para fines de cría de animales por no más de seis horas en cualquier período de 24 horas, y no más de 24 horas en total en cualquier período de 30 días.


A un cerdo reproductor durante el período de cinco días anterior a la fecha prevista de parto del cerdo reproductor, y cualquier día en que el cerdo reproductor esté amamantando lechones.

Durante la investigación médica.




Durante el sacrificio de un animal cubierto de conformidad con las disposiciones del Capítulo 6 (a partir de la Sección 19501) de la Parte 3 de la División 9 del Código Alimentario y Agrícola, relativas a los métodos humanitarios de sacrificio, y otras leyes y reglamentos aplicables.




Durante exhibiciones de rodeo, exhibiciones de ferias estatales o del condado, programas 4-H y exhibiciones similares.







Durante el transporte.
Durante el examen, las pruebas, el tratamiento individual o la operación con fines veterinarios
porciNews A Latina Marzo 2024 | Prop 12: Exigencias normativas para habilitar la exportación de carne de cerdo a California 56 bienestar

RECINTOS NO CONFORMES
Si los animales se mantienen en recintos no conformes durante la gestación no está permitido.
Se deben mantener registros diarios suficiente detalle para documentar que las cerdas reproductoras NO permanecen en recintos no conformes durante más de seis horas por cada período de 24 horas, y no más de 24 horas en total en un periodo de 30 días. 3 CCR sección 1326.2(a) y 1326.2(b)(1)
TRATAMIENTO EN RECINTO NO CONFORME
Si las hembras reproductoras se mantienen en recintos
No conformes para el tratamiento individual, 3 CCR sección 1324.1(a) (2), se debe registrar diariamente por animal, con suficiente detalle, para así documentar que el tratamiento individual es conforme a la ley, y además, bajo la dirección del veterinario del sitio.

ALOJAMIENTO EN MATERNIDAD (RECINTO NO CONFORME A LEY)

La etapa de parto en Maternidades es una excepción de la ley pero, si el recinto es No conforme con el espacio mínimo, el productor debe mantener registros que documenten que:
las cerdas son trasladadas a esos recintos no conformes No más de cinco días antes de la fecha prevista para el parto
Para el destete, la hembra debe ser relocalizada en máx. 6 horas, desde que se realizó el destete ( o la salida de los lechones)
porciNews A Latina Marzo 2024 | Prop 12: Exigencias normativas para habilitar la exportación de carne de cerdo a California 57 bienestar


APERTURA DE MERCADOS
Proposición 12 de California, en teoría, podría considerarse como una opción de apertura de mercado para los productores de cerdos que cumplen con los requisitos normativos.
Cumplir con los estándares de bienestar animal de la Proposición 12 puede permitir que los productores accedan a un segmento de mercado que valora prácticas productivas éticas y que cumplan con el bienestar animal.
Los consumidores cada vez más buscan productos que provengan de sistemas que respeten el bienestar animal y que esto se pueda comprobar a través del cumplimiento de una ley.

DESCÁRGALO EN PDF
Prop 12: Exigencias normativas para habilitar la exportación de carne de cerdo a California 58 bienestar porciNews A Latina Marzo 2024 | Prop 12: Exigencias normativas para habilitar la exportación de carne de cerdo a California
BIENESTAR PORCINO
Encontrarás consejos prácticos para mejorar el bienestar de tus cerdos_

Colaboradora
M. Verónica Jiménez Grez
Médico Veterinario
MSc Etología y Bienestar Animal
Auditora de Bienestar Animal
Instructora de Bienestar Animal


Calendario de vídeos
Enero
Febrero
Marzo
Abril

Mayo
Junio
Julio
Agosto
Septiembre
Octubre
Noviembre
Diciembre
Revive el 2023
Prop 12 en Producción
Porcina. ¿Cumples con los requisitos para exportar a California, EE. UU.?
Bienestar porcino y calidad de carne
Efectos del ambiente sobre el bienestar porcino
¿Cómo mover animales en granja? Consejos prácticos
Aplicación de los 5 dominios en producción porcina
Bienestar Animal y Seguridad Alimentaria
Perspectiva de los sistemas productivos porcinos latinoamericanos y sus principales retos en materia de bienestar
Aspectos económicos de las mejoras relacionadas al bienestar animal
¿Producción en confinamiento o a campo? Pros y Contras
Sitio 1: Alternativas tecnológicas de alojamientos en gestación y maternidad
Inteligencia artificial: aplicación en planta de faena para identificación de lesiones
porcinews.com/abc/abc-bienestar-porcino
¡ NUEVA S E CCIÓN!
EL USO DE GRASAS OXIDADAS EN LA ALIMENTACIÓN
PORCINA: RIESGOS Y CONSIDERACIONES PARTE 1/3
Gerardo Ordaz Ochoa, María Alejandra Pérez Alvarado, Luis Humberto López Hernández
Centro Nacional de Investigación Disciplinaria en Fisiología y Mejoramiento Animal, INIFAP, México
Las grasas y los aceites son componentes esenciales en la dieta de los cerdos, aportan energía, ácidos grasos esenciales, contribuyen a características sensoriales del alimento e inciden en la calidad de la carne (Chen et al., 2018).
Sin embargo, cuando se exponen al oxígeno, la luz y el calor, las grasas pueden sufrir oxidación, lo que provoca cambios en su composición química, sabor y valor nutricional (Nourooz-Zadeh, 1999). Lo cual repercute de manera directa sobre la composición de la dieta, salud de los animales, rendimiento productivo y calidad del producto.


porciNews A Latina Marzo 2024 | El uso de grasas oxidadas en la alimentación porcina: beneficios, riesgos y consideraciones. Parte I 60 nutrición
No obstante, al ser la alimentación de los cerdos un aspecto crítico de la producción porcina desde las perspectivas de producción y economía. En los últimos años, ha habido un creciente interés en la utilización de grasas oxidadas como ingredientes en dietas para cerdos (Chen et al., 2018).
¿CÓMO SE OXIDAN LAS GRASAS?
La oxidación de las grasas se produce mediante una compleja, inicialmente, serie de reacciones químicas que implican la reacción de ácidos grasos insaturados (AGI) con moléculas de oxígeno y radicales libres..
El oxígeno reacciona con los dobles enlaces de los AGI, lo que lleva a la formación de hidroperóxidos lipídicos, que se descomponen aún más en aldehídos, cetonas y otros compuestos volátiles (Frankel, 1980).

El proceso se puede acelerar por otros factores oxidativos como la presencia de catalizadores como metales y enzimas (Frankel, 1980). Por lo que, puede haber auto-oxidación, fotooxidación y oxidación enzimática (Geng et al., 2023).



porciNews A Latina Marzo 2024 | El uso de grasas oxidadas en la alimentación porcina: beneficios, riesgos y consideraciones. Parte I 61 nutrición
La oxidación de los AGI da como resultado la formación de diversos compuestos químicos, mismos que se generan por etapas y que son finitos. Se conoce que la cadena de oxidación está dividida en 3 etapas:
Iniciación
Propagación y Terminación


Las grasas y aceites en general pueden estar en alguna etapa de estas, por ejemplo:
En un aceite fresco, se puede iniciar la oxidación por fotooxidación, caracterizada por la producción de R●, entre ellos, los hidroperóxidos empiezan a ser abundantes.
En la etapa de propagación, un aceite fresco con cierto tiempo de exposición a factores oxidativos, producirá reacciones entre los R● y otros AGI, entre 2 R● y además se producirán moléculas de menor tamaño como el malonaldehído.
En la etapa de terminación, la formación de R● es prácticamente nula, mientras que la producción de moléculas características de la etapa de propagación es casi escasa, dando paso a la producción de moléculas estables o polímeros, que son de diferente naturaleza a la grasa inicial.
¿Puedo juzgar correctamente el potencial oxidativo de la fuente de grasa que usaré en la fabricación de los alimentos?
En México, existen Normas Oficiales (NOM) de carácter obligatorio y opcional (NMX), que dictan las variables a considerar para juzgar la calidad de las grasas y aceites destinados para consumo animal. En muchos casos, complementadas con las destinadas para consumo humano. Sin embargo, estos documentos se basan en evaluar los productos oxidativos de las etapas de Iniciación y Propagación, qué si bien indican un potencial oxidativo mayor por su alta reactividad, no calificarán de manera correcta a aquellas grasas que ya hayan concluido estas etapas de oxidación.
En muchos casos, valores bajos de peróxidos (hidroperóxidos), no son representativos de la calidad de una grasa con mayor avance en la oxidación. Siendo necesario incluir, en el mejor de los casos, la determinación de las Sustancias Reactivas al Ácido Tiobarbitúrico (TBARS).

Sin embargo, valores bajos de peróxidos y de TBARS, son también característicos de grasas que están en la etapa de Terminación de la oxidación, siendo indicadores de calidad pobremente interpretados, lo que obliga al medio a buscar determinaciones que deban incluir los productos de la fase de Terminación.
porciNews A Latina Marzo 2024 | El uso de grasas oxidadas en la alimentación porcina: beneficios, riesgos y consideraciones. Parte I 62 nutrición

LAS GRASAS OXIDADAS EN LA ALIMENTACIÓN PORCINA
Los compuestos de toda la cadena de oxidación inducirán sabores desagradables, rancidez y una vida útil reducida, afectando directamente al alimento final.
Además, la oxidación disminuirá la calidad nutricional de las grasas, al reducir los niveles de ácidos grasos esenciales y vitaminas liposolubles (Nourooz-Zadeh, 1999).

Las grasas oxidadas afectarán la palatabilidad del alimento, la digestibilidad de los nutrientes y el rendimiento productivo del cerdo. Los altos niveles de productos de la oxidación (Iniciación y Propagación) pueden comprometer la calidad nutricional de los ingredientes del alimento y presentar riesgos para la salud de los animales (Cherian & Jacob, 2006)
De acuerdo con lo reportado sobre el uso de grasas oxidadas en la alimentación porcina existen controversias sobre su incorporación. En la literatura se pueden encontrar resultados discrepantes, entre los riesgos y paradójicamente beneficios.

Los riesgos reportados sobre el uso de grasas oxidadas en la alimentación porcina se agrupan en tres:
Las grasas oxidadas pueden contener niveles reducidos de vitaminas liposolubles y antioxidantes debido al proceso oxidativo.
Los cerdos alimentados con dietas ricas en grasas oxidadas pueden correr riesgo de sufrir deficiencias de nutrientes, en particular de vitamina E, que desempeña un papel crucial en la defensa antioxidante y la función inmune (Nguyen et al., 2019).
Las grasas oxidadas pueden impartir sabores y olores desagradables al alimento, afectando potencialmente el consumo de alimento.
La presencia de subproductos oxidativos puede dificultar la digestión y absorción de grasas, lo que lleva a una reducción de la utilización de nutrientes y del rendimiento en el crecimiento (Chen et al., 2018).
El consumo de grasas oxidadas se ha asociado con efectos adversos para la salud en los animales, incluido el estrés oxidativo, la inflamación y la función inmune comprometida.
Los cerdos alimentados con dietas que contienen altos niveles de grasas oxidadas pueden ser más susceptibles al daño oxidativo y a los trastornos metabólicos (Jha & Berrocoso, 2016).
nutricionales
Implicaciones
Palatabilidad y digestibilidad Salud
63 nutrición porciNews A Latina Marzo 2024 | El uso de grasas oxidadas en la alimentación porcina: beneficios, riesgos y consideraciones. Parte I
Sin embargo, para los porcicultores la información es incompleta, llegándose a considerar beneficios erróneos como:
Rentabilidad
Fuente de energía

A pesar de la formación de los subproductos oxidativos, estas grasas retienen una parte importante de su valor calórico (Gourle et al., 2020). Valor desconocido y más cuando existe una alta variabilidad de fuentes en el mercado nacional.

El costo beneficio, aparentemente se mejora, al ser una fuente de energía más barata que grasas o aceites de buena calidad, pero sin información de respaldo.
En este punto, entra la reutilización, ya que, al ser una problemática de la industria alimentaria, la disponibilidad es mayor y el costo menor (Gourle et al., 2020).
porciNews A Latina Marzo 2024 | El uso de grasas oxidadas en la alimentación porcina: beneficios, riesgos y consideraciones. Parte I 64 nutrición
CONSIDERACIONES
Las grasas oxidadas exhiben características distintas que resultan de la oxidación de los AGI.

Cabe destacar que los actuales indicadores de oxidación, no precisamente son apropiados para la calidad de grasas que son destinadas al consumo animal, por lo que se deben establecer límites a la inclusión de grasas oxidadas en los alimentos para cerdos, a fin de garantizar la seguridad y calidad del producto final.

Los cambios químicos durante la oxidación conducen a la formación de compuestos que afectan el sabor, el aroma y las propiedades nutricionales de las grasas. Siendo las acroleínas y las acrilamidas, subproductos derivados del antraceno, de alto riesgo para la salud.
En los siguientes volúmenes de porciNews se abordarán los efectos que tiene el uso de grasas oxidadas en la alimentación de reproductores (Parte 2), así como, en los cerdos en línea de producción (Parte 3).
La inclusión de grasas oxidadas en la alimentación del cerdo requiere cuidadosas consideraciones en la formulación y tiempo de uso, sin embargo, se deben ponderar los riesgos asociados al uso de grasas oxidadas.
El uso de grasas oxidadas en la alimentación porcina: beneficios, riesgos y consideraciones. Parte I.
DESCÁRGALO EN PDF
DESCARGAR BIBLIOGRAFÍA


porciNews A Latina Marzo 2024 | El uso de grasas oxidadas en la alimentación porcina: beneficios, riesgos y consideraciones. Parte I 65 nutrición


EXPLORANDO LA MICROBIOTA Y BIOMARCADORES DE SALUD INTESTINAL
Guillermo
Ramis Veterinario y Profesor Titular de la Universidad de Murcia

1
PUNTOS A TENER EN CUENTA
2
La integridad intestinal se define como el mantenimiento de la estructura histológica que regula la internalización de moléculas a través de la mucosa del intestino. El grave inconveniente de la pérdida de integridad intestinal es que se pierde el control de esta absorción
Cualquier molécula podría ser un biomarcador si conocemos las condiciones en las que cambia, si aumenta o disminuye, en qué medida cambia y si existe un umbral para identificar ese cambio. También debe ser de fácil detección, económico y producir resultados consistentes ante el mismo cambio.
porciNews A. Latina Marzo 2023 | Explorando la microbiota y biomarcadores de salud intestinal microbiota 66
3

4
La microbiota es un tema crucial en la investigación de humanos y animales. Se introduce el concepto de “holobionte”.
Ahora ya no entendemos un cerdo como individuo, sino que consideramos que se trata de un conjunto de relaciones con todas las especies que alberga dicho mamífero en la piel, boca, digestivo, respiratorio, piel, vagina, etc.
¿Qué podemos esperar en el futuro?
Tal vez estemos en el momento de empezar a ver vacunas Smart, en las que se busquen concretamente las cepas que tiene una granja y se incluyan solo esos antígenos.
En este sentido, estamos a punto de iniciar la revolución de la probiosis dirigida y específica, que consiste en conocer qué microbiota tienen los animales, qué mejor producen y qué mejor integridad intestinal muestran.
Esto nos permitirá seleccionar cepas de bacterias o levaduras presentes en estos animales y ausentes en los enfermos.

LA INTEGRIDAD INTESTINAL Y LOS BIOMARCADORES
La integridad intestinal se define como el mantenimiento de la estructura histológica que regula la internalización de moléculas a través de la mucosa del intestino, primándose la absorción transcelular sobre la paracelular.
Esto permite que las células epiteliales regulen qué moléculas pueden acceder al interior del animal mediante canales, receptores o transportadores.
Por la vía paracelular, sin embargo, solo pasan agua, algunos cationes y pequeñas moléculas.
El grave inconveniente de la pérdida de integridad intestinal es que se pierde el control de esta absorción, es decir, se rompen las uniones estrechas (TJ por las siglas en inglés de Tight Junctions) que son un conglomerado de proteínas que mantienen unidos los enterocitos entre sí, permitiendo el paso paracelular de elementos como virus, toxinas, bacterias o proteína sin digerir que podrían actuar como antígeno.
porciNews A. Latina Marzo 2023 | Explorando la microbiota y biomarcadores de salud intestinal microbiota 67
Este fenómeno ligado a la pérdida de integridad intestinal conlleva, en la mayoría de los casos, una activación del sistema inmunitario.
En unos casos necesaria y en otro no, pero que siempre conlleva el consumo de energía y recursos que se detraen del crecimiento de los cerdos, pudiendo generarse un círculo vicioso que produciría una retroalimentación de esta reacción.
Los principales actores son las células efectoras y las citocinas, como moléculas de señalización.
Sabemos que la pérdida de integridad intestinal se relaciona con sobreexpresiones de IFN-γ, TGFβ, TNFα, entre otras.
Estas moléculas dirigirán la respuesta inmunitaria hacia un componente celular, humoral o mixto.
Una de las preguntas clave es, ¿cómo medimos el nivel de integridad intestinal o de activación inmunitaria en el intestino?
Utilizaremos lo que se conoce como biomarcadores.
Un biomarcador es cualquier molécula que podamos medir, que cambie en una determinada circunstancia fisiológica o patológica y que sepamos en qué dimensión y sentido cambia (aumentando o disminuyendo).
Otra cuestión es ¿qué matriz usamos para determinar esos biomarcadores?

En este punto podemos usar las más invasivas (tejidos), que requieren el sacrificio del animal, o las invasivas, que son aquellas que requieren una toma de muestras que impliquen agujas, como es la sangre.
También existen las técnicas no invasivos, que utilizan matrices obtenidas de forma natural como son las heces o la orina.
porciNews A. Latina Marzo 2023 | Explorando la microbiota y biomarcadores de salud intestinal microbiota 68
Otro elemento a analizar es ¿qué queremos determinar?
Podemos buscar una proteína o un azúcar, un ARN que nos indique una expresión génica (si el gen para un biomarcador se está expresando más o menos). Incluso podemos suministrar nosotros un elemento con una ruta de absorción conocida para luego determinar cuánta cantidad se ha absorbido.
Esto último es lo que se denomina pruebas de permeabilidad intestinal y permiten estimar si la vía paracelular está más abierta en un grupo de animales que en otro.

+ invasivas
TEJIDOS
Si empezamos por las muestras más invasivas, estaremos hablando de tejidos, lo que, en la mayoría de los casos, implicará el sacrificio de los animales.
Y esto, desde el punto de vista del bienestar y la ética, cada vez está peor visto, además de suponer un coste muy elevado.
Pero ahora se plantea otra cuestión: ¿Qué muestras usamos?
Desde luego, la respuesta depende del nivel de invasión que deseemos.
El segundo nivel de invasión sería la toma de fluidos mediante punción, como es el caso de la sangre y que no implica el sacrificio del animal.
Finalmente las menos invasivas, que serían la orina (si se obtiene sin sondaje) y las heces
- invasivas
porciNews A Latina Marzo 2024 | Explorando la microbiota y biomarcadores de salud intestinal microbiota 69
.
FLUÍDOS EXCRETAS
En nuestro laboratorio hemos apostado por las muestras mínimamente invasivas por lo que, generalmente, trabajamos con heces, y en ellas determinamos la cantidad de ARNm que hay para estimar tanto la integridad intestinal (cuantificando el ARNm para las proteínas de las TJ), como la estimulación inmunitaria (cuantificando el ARNm para las citocinas).
Las heces no nos permitirán establecer específicamente qué ocurre en cada tramo del intestino, pero son un indicador del estado general del mismo y se han utilizado ampliamente con anterioridad en distintas experimentaciones (Ramis et al., 2023; Sánchez-Uribe et al., 2022; Bravo de Laguna et al., 2022; Ramis et al., 2022; de Groot et al., 2021; de Groot et al., 2022).
¿QUÉ DEBEMOS SABER DE LOS BIOMARCADORES DE SALUD INTESTINAL?
Y ahora, hablemos de biomarcadores. Para empezar, definamos un biomarcador: será toda molécula que cambie alguna circunstancia fisiológica y patológica.
Potencialmente, toda molécula podría ser un biomarcador siempre y cuando sepamos:
En qué circunstancias cambia; si aumenta o disminuye dependiendo de esa circunstancia,
en qué dimensión cambia y si hay un umbral que nos permita saber si se está produciendo ese cambio.
Además, debería ser fácil de determinar, barato y que siempre produzca el mismo resultado ante el mismo cambio. Esto es realmente difícil y por eso solo hay unas pocas moléculas que nos permitan usarlas como biomarcadores.

porciNews A Latina Marzo 2024 | Explorando la microbiota y biomarcadores de salud intestinal microbiota 70
ARNm
En nuestro caso, para determinar la integridad y permeabilidad intestinal, usamos el ARNm de las proteínas de uniones estrechas.
Si usáramos la propia proteína, podríamos encontrarla en sangre dado que cuando se rompen las TJ una parte de esta proteína se trasloca y la encontraríamos aumentada.
Sin embargo, al estudiar el ARNm, esperamos encontrar mayor cantidad en los animales que mejor integridad intestinal tengan, dado que una cantidad alta de ARNm indicaría que se produce una reposición adecuada de estas proteínas.

Entre estas estudiamos la zonulina, ocludina y claudina como tres de las más importantes entre todas las que componen las TJ.
Calprotectina
Otro biomarcador interesante que se usa ampliamente en humanos es la calprotectina.
Esta proteína se encuentra en macrófagos y neutrófilos, por lo que es un indicador de infiltrado celular en la mucosa intestinal. En este caso se puede determinar la proteína o el ARNm en las heces.
El problema de la proteína es que no existe un estándar establecido en cerdos o un umbral que indique que la infiltración celular es elevada, cosa que sí se tiene en humanos.

Citocinas
Finalmente, tenemos todas las citocinas, que serían un indicador de activación inmunitaria y que incluso nos permitiría determinar si está predominando la inmunidad innata, la Th1, la Th2, o hay una reacción mixta.
Entre estas tendremos las principales proinflamatorias (IFNα, IFNγ, IL1α, Il1β, IL4, IL6, IL8, TNFα) o antiinflamatorias (TGFβ o IL10). La relación entre ambos grupos nos permitirá establecer si el animal está en una situación proinflamatoria y antiinflamatoria.
Estos biomarcadores nos han permitido saber qué cambios se producen cuando se usan elementos de protección como el óxido de zinc, las vacunas, distintos aditivos como enzimas, lignanos, fermentados de cereal o incluso fuentes de zinc alternativas, como los quelados o los microencapsulados, así como numerosos aditivos naturales (polifenoles, triterpenos, distinto ácidos orgánicos) y, como no, probióticos, prebióticos y simbióticos.
porciNews A Latina Marzo 2024 | Explorando la microbiota y biomarcadores de salud intestinal microbiota 71
TODO SOBRE LA MICROBIOTA
Hoy en día, la microbiota constituye uno de los principales focos de estudio en humanos y animales.
Desde hace algún tiempo se empieza a manejar el concepto de “holobionte” y ya no entendemos un cerdo como individuo sino como un conjunto de relaciones con todas las especies que alberga dicho mamífero en la piel, boca, digestivo, respiratorio, piel, vagina, etc. que pueden llegar a ser entre 500 y 1.000.

El conjunto del mamífero y todas estas especies de bacterias, virus, levadura, hongos e incluso protozoos tiene una interrelación muy profunda y el equilibrio entre ellos, el hospedador, el ambiente y la nutrición, es crítica para que el animal esté en un estado de salud adecuado. Y además interaccionan con el medioambiente de una forma definitiva.
hospedador
ambiente nutrición

Se han hecho numerosos estudios de microbiota y a veces obtener información de estos estudios es complicado.
Hoy tenemos claro que la diversidad es crítica para que el equilibrio con el mamífero sea adecuado.
Pero también sabemos que cambia muy rápido y que incluso se pueden establecer ritmos circadianos en la predominancia de determinadas especies o incluso variedades dentro de una misma especie.
¿CÓMO RELACIONAMOS ESTO CON LA INTEGRIDAD INTESTINAL Y LOS BIOMARCADORES?
Parece claro que la composición de la microbiota es clave para mantener la salud intestinal, empezando por mantener la integridad intestinal. De hecho, el concepto de desequilibrio o disbiosis lo manejamos hace décadas.
Cuando se produce un desequilibrio entre las especies que son saprofitas y aquellas que son potencialmente patógenas. Estas últimas son capaces de proliferar en exceso y ejercer su acción patogénica.

Y en algunos casos esto empieza por una pérdida de integridad intestinal, producida por la propia disbiosis o inducida por ella.
porciNews A Latina Marzo 2024 | Explorando la microbiota y biomarcadores de salud intestinal microbiota 72

Es complicado establecer una relación entre microbiota y TJ, y no hay mucha bibliografía al respecto, pero sin duda, esta relación debe existir.
No en vano, tenemos indicadores indirectos de que un mal estado de salud intestinal propiciado por especies como E. coli influye directamente en la integridad intestinal:

El ejemplo del incremento de estreptococias cuando tenemos problemas de colibacilosis o cuando se retiraron los antibióticos preventivos frente a esta enfermedad es un ejemplo clave.
Sabemos que S. suis utiliza la translocación a través de un intestino débil para alcanzar sus tejidos diana.
Pero aún no tenemos claro qué familias y qué género son especies que tienen una influencia directa sobre estas TJ.

Pues al igual que estamos en el momento de empezar a ver vacunas Smart, donde se busquen específicamente las cepas que tiene una granja y se incluyan solo esos antígenos, estamos a punto de iniciar la revolución de la probiosis dirigida y específica: Conocer qué microbiota tienen los animales que mejor producen y mejor integridad intestinal muestran nos permitirá seleccionar cepas de bacterias o levaduras presentes en estos animales y ausentes en los enfermos o los que peor produzcan, cultivarlas y suministrarlas a los lechones.
Pero esto es una historia para el futuro...
 DESCÁRGALO EN PDF
DESCÁRGALO EN PDF
porciNews A Latina Marzo 2024 | Explorando la microbiota y biomarcadores de salud intestinal microbiota 73
Explorando la microbiota y biomarcadores de salud intestinal
Una visión técnica e innovadora del sector porcino en América Latina...
¡A un click de distancia!

¡Suscríbete!
www.porcinews.com
/porcinewslatam
















































 Figura 3: Longitud HDD (distancia de difusión hemotrófica) de los lados materno y fetal de la interfase a los 25 días; HDD = 11,4 µm (a), 40 días; HDD = 15,94 µm (b), 60 días; HDD = 7,42 y 3,72 µm (c) y 114 días; HDD = 2,46, 1,93 y 1,62 µm (d). Se observa una disminución de la altura de la capa celular del epitelio endometrial (columnar). BV, venas; EG, gránulos electrodensos; FM, mesénquima fetal; F/M I, interfase materno-fetal; MV, microvellosidades; StE, estroma; EU, epitelio uterino. Escala: 5 µm. Cristofolini et al. (2017).
Figura 3: Longitud HDD (distancia de difusión hemotrófica) de los lados materno y fetal de la interfase a los 25 días; HDD = 11,4 µm (a), 40 días; HDD = 15,94 µm (b), 60 días; HDD = 7,42 y 3,72 µm (c) y 114 días; HDD = 2,46, 1,93 y 1,62 µm (d). Se observa una disminución de la altura de la capa celular del epitelio endometrial (columnar). BV, venas; EG, gránulos electrodensos; FM, mesénquima fetal; F/M I, interfase materno-fetal; MV, microvellosidades; StE, estroma; EU, epitelio uterino. Escala: 5 µm. Cristofolini et al. (2017).


 Figura 5: Representación de los conceptus porcinos hembra (rosa) y macho (azul) en el entorno intrauterino. Adaptado de Stenhouse, Bazer y Ashworth (2022)
Figura 5: Representación de los conceptus porcinos hembra (rosa) y macho (azul) en el entorno intrauterino. Adaptado de Stenhouse, Bazer y Ashworth (2022)

DESCÁRGALO EN PDF
DESCÁRGALO EN PDF
